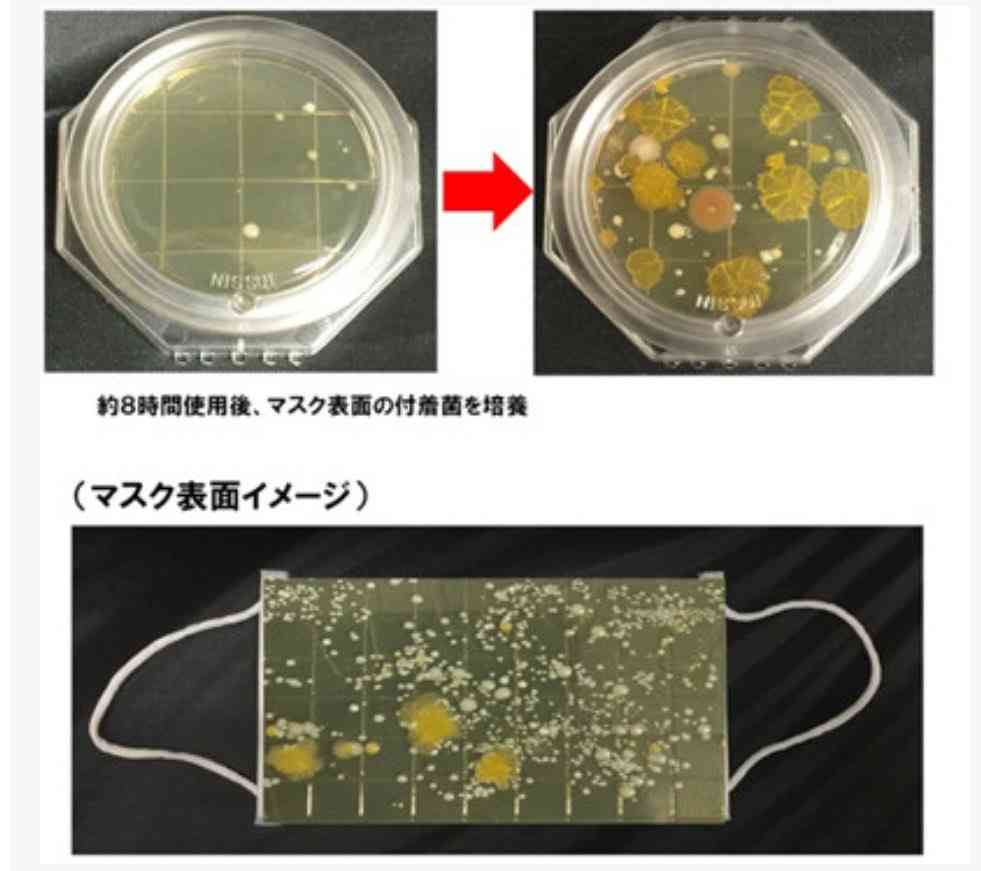
東京都で新たに339人の感染確認 5日ぶり300人超 重症者は4人増え36人

-
2001. 匿名 2020/08/21(金) 00:08:59
>>1995
食べな+3
-0
-
2002. 匿名 2020/08/21(金) 00:09:54
>>1974
ユニクロとかまさに
そうなるとブランドはやばそうだね
閉店ラッシュきそう+6
-0
-
2003. 匿名 2020/08/21(金) 00:10:26
>>2000
当たり前だろ
タダの風邪ごとき気にしてられるか+4
-9
-
2004. 匿名 2020/08/21(金) 00:10:27
>>2000
コロヒスって予防してる人達の事じゃないでしょ。むやみやたらに自粛強要してくる人達の事だよ。
自粛否定派だって最低限の予防はしてる人が殆ど。+12
-1
-
2005. 匿名 2020/08/21(金) 00:11:03
命を全部は守れないように店や企業も全部は守れない+3
-0
-
2006. 匿名 2020/08/21(金) 00:11:11
>>1972
コロヒスって本当にいるの?
私の周りはいないから都市伝説に感じててw
何されたの?+5
-1
-
2007. 匿名 2020/08/21(金) 00:12:21
>>2000
ここに書いたらマイナス食らったんだけど
私の生活ってコロヒスさんには理解出来ないくらい充実してるみたいw+6
-3
-
2008. 匿名 2020/08/21(金) 00:12:38
>>2003
そういう人が用心しながら店開けてる人達の足も引っ張ってる+9
-1
-
2009. 匿名 2020/08/21(金) 00:13:23
>>2008
その開けてる店のお客さんでしょ?+2
-1
-
2010. 匿名 2020/08/21(金) 00:13:23
百貨店、ショッピングモールの次は駅ビルの時代来るって言われてたけど来なそうだね
案外テレワーク可能でしたって企業三割いたようだから
首都圏の三割の企業って数としては相当だし、通勤者にも影響あるし、駅近くのアフターファイブの習い事やスポーツジムもヤバイ+8
-2
-
2011. 匿名 2020/08/21(金) 00:14:23
>>2009
主語はなに+3
-1
-
2012. 匿名 2020/08/21(金) 00:14:24
>>2002
確かにブランド系はヤバいよね
近年コスパ買いのせいで、元もとヤバかったのが追い打ち
まー、元メーカー勤務してたから言うと、同じ工場で作ってるのにブランドタグつけただけで10倍価格にするような世界だから仕方ないけど
ヴィトンみたいな自社工場ブランドは別ね+8
-0
-
2013. 匿名 2020/08/21(金) 00:15:44
>>1958
咳やクシャミしなきゃいいけどね。
+7
-0
-
2014. 匿名 2020/08/21(金) 00:16:57
熱が下がっても味覚、嗅覚障害がしばらく続く人が多い、不思議な病気だわ。+2
-4
-
2015. 匿名 2020/08/21(金) 00:16:59
>>2012
最近は確かにデザインパクるというのは聞いたことある
ヴィトンみたいなのは意外と根強いファンがいるし、材質など確かめるために店舗で買いたい人多いから一定の需要あるよね
あの辺のだと、鞄だとか20万はするし流石にネットで買いたいとは思わないものww+3
-0
-
2016. 匿名 2020/08/21(金) 00:17:08
>>1952
旅費50万くらいあればいけるよー!
旅行だったらいいところだよー+1
-0
-
2017. 匿名 2020/08/21(金) 00:17:52
>>2004
真上の2003に一部の変な奴がいる
こういうマスクしねーよ!な奴がイメージ下げるよね+4
-0
-
2018. 匿名 2020/08/21(金) 00:18:03
>>1981
あちらはインセンティブがあるため、他の死因もすべてコロナとして報告すると報酬が高くなります。日本でもコロナ以外の死因であってもコロナと書くよう通知があったことはご存知ないですか。
超過死亡はありません。アメリカではサメに噛まれて死んでPCR陰性でも新型コロナの死者に数えられています。(フランスはPCR陽性となった者と同じオフィスで働いていた者は検査をしなくてもみんな新型コロナです)
アメリカの救急医療のドクターの話
Dr. Simone Gold on Twitter: "After our press conference, I was defamed by the media, censored by social media companies, terminated from employment, and viciously attacked, all for advocating for the right of physicians to prescribe what they believe is btwitter.com+2
-4
-
2019. 匿名 2020/08/21(金) 00:18:26
>>2004
私、自粛強要する人も自粛すんな経済回せーって強要する人もガルちゃん以外で見たことないw+6
-0
-
2020. 匿名 2020/08/21(金) 00:18:27
COVIDに関しての新たな知見が全然出てこないのはなぜ?+1
-0
-
2021. 匿名 2020/08/21(金) 00:18:29
コロナトピの伸びも悪くなってきてるしネットでもリアルでも経済回す派どんどん増えてってるし皆メディアの洗脳から目覚めてってる感じ?+10
-3
-
2022. 匿名 2020/08/21(金) 00:18:44
>>1386
どういうこと?+0
-0
-
2023. 匿名 2020/08/21(金) 00:18:59
横だけど、こうゆう時にスピ系の人コロナの終息するとか分からないのかな。いつ頃落ち着くとか。+2
-2
-
2024. 匿名 2020/08/21(金) 00:19:16
>>1397
なぜこれマイナスなんだろう。
寿命のうちに入ると思うけどな+5
-4
-
2025. 匿名 2020/08/21(金) 00:19:38
>>2003
さすがにそろそろ気にしたほうが良い
変異する頃だよ+2
-6
-
2026. 匿名 2020/08/21(金) 00:19:38
>>1227
中国よりっていうか完全リベラルだよね。
最近YouTubeで真実語れないよくテレビに出てた人達がシフトチェンジなのか使い分けなのかバンバンYouTube移行してる。
ガルちゃんに降臨した自称放送作家の卵さんがコロナネタは数字が取れるって言ってたけどさ、見る価値なんかないのよ。
どうせ出してるスポンサーもあっちよりなんでしょ。+7
-0
-
2027. 匿名 2020/08/21(金) 00:19:51
毎日同じテーマでトピ立てしているからだけど
いいかげん書くネタも尽きたよね
コメント数も減ってきているし
+6
-0
-
2028. 匿名 2020/08/21(金) 00:20:07
>>2019
自粛強要する人は周りにもいないなー
私も働いてるし周りも30代だから生活のほうが重要+8
-0
-
2029. 匿名 2020/08/21(金) 00:20:08
>>1537
働いてますよー
医療崩壊したら私達がもし感染した時に
自宅待機して医療難民になるんだよ。
政府の無対策に医療従業者は怒りを露わにしてるの
が分からないのかな。
安心して生活出来ないうちは経済なんて回るわけない。
健康だったら経済が落ち込んでも復活することは出来る。
+5
-11
-
2030. 匿名 2020/08/21(金) 00:20:24
>>2023
いないよ、そんな人。+1
-0
-
2031. 匿名 2020/08/21(金) 00:20:35
>>2021
自粛してもウィルスなくならないからでしょう
+8
-0
-
2032. 匿名 2020/08/21(金) 00:20:36
>>2010
通勤ラッシュの緩和を目指してたから、駅ビルの時代が来るって言われていたのも変な話だなぁと思うわ。+0
-0
-
2033. 匿名 2020/08/21(金) 00:20:45
こんな時に転職活動中で、3日くらい前に都内まで出て。
昨日朝起きたら突然胸付近が痛くて、体温も高くてって状態で。ついに、って思ったけど。治った。
本当明日は我が身って感じだよね。+3
-0
-
2034. 匿名 2020/08/21(金) 00:21:35
新コロ教徒はクラスターが新型コロナ特有の恐ろしい特性と思ってますが、風邪のクラスターなんか毎年無数に発生してるのにね+6
-0
-
2035. 匿名 2020/08/21(金) 00:21:49
>>2027
でも未だに少なくても千件行くのはすごいよ+0
-0
-
2036. 匿名 2020/08/21(金) 00:21:49
>>882
>>874
無症状の感染者かもよ?+2
-2
-
2037. 匿名 2020/08/21(金) 00:22:48
>>1977
コロナの始まり。世界の終わり。+1
-0
-
2038. 匿名 2020/08/21(金) 00:22:57
今日も大阪多かったの?+1
-0
-
2039. 匿名 2020/08/21(金) 00:23:20
>>1600
そもそも中国になんてコロナよりずっと前から既に買い叩かれてる。政府や自治体はほぼ無策。
それを今更、go to みたいな中途半端な延命処置でどれほどの効果があるわけ?
本気でやるなら 法的に規制できるようにでもしないと、と思うけど、今の政府はできないだろうね。
+5
-0
-
2040. 匿名 2020/08/21(金) 00:23:44
【武田邦彦 8/19発表】ついに終結です! 明日からマスクはどうしたらいいの?それについても もちろんお話しします! - YouTubeyoutu.be【公式】DHCテレビ 最新出演動画! https://youtu.be/tsuYEkvoHUg 【公式】武田邦彦の「ホントの話。」PCR開発者キャリー・マリス ムーンショット計画 他 https://youtu.be/qJTNLHxzarc [公式] ニューソク通信社 最新出演動画! https://youtu....
テレビが不必要にコロナを煽っていますよね+2
-1
-
2041. 匿名 2020/08/21(金) 00:24:01
>>2038
132人!
もう収束したよ👍+4
-0
-
2042. 匿名 2020/08/21(金) 00:24:24
>>2032
通勤者だけでなく、出張者が駅ビルならさっとお土産なり買っていけてアクセス良いし、忙しい人でも立ち寄りやすいだろうということで期待されてたようだよ
ただ肝心の出張も減りそうだから終息したら需要ないわけではないけど当初よりは見込めないだろうな+1
-0
-
2043. 匿名 2020/08/21(金) 00:24:41
>>1863
コロナよりおばちゃんが怖いよー+1
-0
-
2044. 匿名 2020/08/21(金) 00:25:04
>>2029
勝手な事言うねー。日本国民全員が貯金切り崩して生活できると思ってんの?
それにどうしても現場で働かなくちゃいけない、スーパー等の接客や配達員、その荷物を梱包配送する人達の安全はどうするの?
こういう書き込み本当に腹が立つ!無責任すぎでしょ。
それともまた買いだめさせる気?それこそ三密でしょ。
なんでなんでもかんでも自分の言う通りに従わせようとするわけ?社会主義者かなんかなの?+9
-2
-
2045. 匿名 2020/08/21(金) 00:25:09
>>2028
わたしも。
ただ、マスク外しなよって言われたことはある
ビビッた+0
-2
-
2046. 匿名 2020/08/21(金) 00:25:25
>>2024
寿命というなら若くして残念な結果になっても寿命だわ。+5
-0
-
2047. 匿名 2020/08/21(金) 00:25:28
>>1952
ニュージーランドもロックダウン失敗だったと気付いたので方向転換かな?
NZのコロナ都市封鎖 一部で国民の権利と自由を違法に制限と判断 - ライブドアニュースnews.livedoor.comNZのコロナ都市封鎖 一部で国民の権利と自由を違法に制限と判断 - ライブドアニュース ライブドアニュースドアふみ NZのコロナ都市封鎖、一部違法 裁判所は「必要な対応」とも指摘2020年8月19日 19時53分共同通信 【シドニー共同】ニュージーランドの裁判所は19日...
+3
-4
-
2048. 匿名 2020/08/21(金) 00:25:37
>>2041
収束…でいいのか?
感染者数教えてくれてありがとう。+4
-1
-
2049. 匿名 2020/08/21(金) 00:26:37
>>2046
ん?
ちょっと意味が分からない+0
-0
-
2050. 匿名 2020/08/21(金) 00:27:03
>>2006
私の周りにもコロヒスな人いないけど。
ガルでは多いよね。
自粛ばかり言う人。
そりゃ大勢で集まって大騒ぎするのは、躊躇するけど
予防して動くならいいと思うけどなぁ。
+5
-2
-
2051. 匿名 2020/08/21(金) 00:27:42
>>2045
マスクしろよじゃないんだ!w
ガルちゃんはある意味面白いけど同じテンションで人と会うと私がコロヒスになっちゃうから気をつけてるw(自称経済派)+1
-0
-
2052. 匿名 2020/08/21(金) 00:27:44
>>2023
スピじゃないけど、
世界政府を作るのが最終目標だからコロナは人をコントロールする為の駒でしかない。ウイルスを強めたり弱めたりは人々の反応見ながら決めてると思われる。恐怖を植え付けるとコントロールしやすいから。何年後に終わる、ではなく終わるとすればいかに早く庶民達が上の言う事に従順になるかにかかってるんだと思う
陰謀論からは以上です。+1
-1
-
2053. 匿名 2020/08/21(金) 00:27:50
>>2037
本当に世界が終わるまでは...
の瀬戸際だ+4
-0
-
2054. 匿名 2020/08/21(金) 00:27:56
>>2050
ここのスレは専業主婦が多いからしょうがないよ+4
-4
-
2055. 匿名 2020/08/21(金) 00:28:07
>>2040
マスクはインフルシーズンまで付けててー+3
-1
-
2056. 匿名 2020/08/21(金) 00:28:08
>>77
慣れって怖いよね。+1
-0
-
2057. 匿名 2020/08/21(金) 00:29:00
もう緊急事態宣言は出ないんでしょうか、、+2
-5
-
2058. 匿名 2020/08/21(金) 00:29:20
>>2054
しかも子育て終わった50オーバーの人も多い
だから生活困ってない+10
-3
-
2059. 匿名 2020/08/21(金) 00:30:02
>>28
熱中症で死亡の3分2は室内でクーラーつけてないせいだから
外も首に保冷剤入りタオルでも巻いて、水分補給等面倒がらずに対策したらいいでしょ。+16
-2
-
2060. 匿名 2020/08/21(金) 00:30:43
各国でワクチンをどういう風に使うか議論が始まってるね
生産体制そっちのけで全国民に義務化すると言ったり、アメリカだと黒人とラテン系の死亡率が高いから先に接種させようとか
インドは人口とカーストで大変そう…+1
-0
-
2061. 匿名 2020/08/21(金) 00:30:44
>>2021
目覚めてる人は増えてきてるけど、情報弱者は気づいてない。
ガルにもいるけど、マイナス思考に陥りやすいイラつくほど前向きになれない人はまだ自粛自粛言ってる。
コロナの事だけピックアップして、悲壮感に陥って可哀想な自分に浸ってる奴らね。
もっとちゃんと世界情報集めなさいと思う。
渋谷勤務の私が思ってる。+14
-7
-
2062. 匿名 2020/08/21(金) 00:30:50
>>2057
経済が瀕死になり企業が倒産し、公的制度も崩壊に近づくので簡単には出来ません
年金制度も医療制度も崩壊に近づきます+9
-2
-
2063. 匿名 2020/08/21(金) 00:31:07
>>2048
重傷者は60人で東京のほぼ倍だ。安心してけろ。+4
-1
-
2064. 匿名 2020/08/21(金) 00:31:34
>>2057
出たらそのときは逝く候補になります+2
-0
-
2065. 匿名 2020/08/21(金) 00:32:18
>>2018
えっ?超過死者数は増えてるよ?ありませんってどういうこと?+1
-0
-
2066. 匿名 2020/08/21(金) 00:32:47
>>2057
早く出さないと、手遅れになるよね。
既に手遅れかも+1
-13
-
2067. 匿名 2020/08/21(金) 00:33:06
>>2047
あららら…どうなるかね+3
-0
-
2068. 匿名 2020/08/21(金) 00:33:33
>>2066
出したら財政的に困難で手遅れですけどね+4
-0
-
2069. 匿名 2020/08/21(金) 00:33:48
>>73
中国マフィアの巣窟になったら嫌だな。+3
-0
-
2070. 匿名 2020/08/21(金) 00:33:51
>>2057
緊急事態宣言とか意味なしw+8
-1
-
2071. 匿名 2020/08/21(金) 00:35:02
>>2062
もうかってる所は儲かってるんだし
任天堂やヤマトみたいねに。
時代の波についていけなかっただけ。
また、時代に合う企業が進出してくるよ。
それが経済+6
-6
-
2072. 匿名 2020/08/21(金) 00:35:28
>>2057
それほどひどいのないよね
日本は要請で禁止ではないから補償が曖昧で出す義務ないし、営業したら罰則になるし仕事やる方からしたら迷惑な話だと思う+4
-0
-
2073. 匿名 2020/08/21(金) 00:35:31
>>2057
うちはまだまだ心配ないけど、それまでに企業がバタバタ倒れるから反対
緊急事態宣言出したい層ってどんなよw+3
-0
-
2074. 匿名 2020/08/21(金) 00:35:56
>>2057
煽るよねーw+2
-1
-
2075. 匿名 2020/08/21(金) 00:36:05
コロナの真実を知っているから(無症状だとのどに引っ付いているレベル)の可能性が高いのだろうな。
感染看護師勤務のクリニック、患者二十数人が「症状ない」と検査辞退(読売新聞オンライン) - Yahoo!ニュースnews.yahoo.co.jp三重県が18日に発表した新型コロナウイルスの感染者は計3人で、県発表の感染者は延べ288人となった。3人のうち、津市の90歳代の無職女性は「あらき内科クリニック」(津市)の患者で、クリニックのクラ
+2
-1
-
2076. 匿名 2020/08/21(金) 00:36:05
>>2047
却下された日本とは大違い
日本人でよかった+2
-0
-
2077. 匿名 2020/08/21(金) 00:36:12
>>2071
任天堂は今だけ
ヤマトはいいかも!+2
-0
-
2078. 匿名 2020/08/21(金) 00:36:20
>>2061
若いか若くないかじゃない?
私はアラサーだから死にはしないと思って働いてるけど、親は怖がってるから私も会わないよ
50代以上には怖いもんだからね
自粛するなって無理強いするのもねーとは思う+4
-1
-
2079. 匿名 2020/08/21(金) 00:36:43
封じ込めなど無理でしょうね。
世界の流れはスエーデン方式ですから。
いつまでやってるんですかね…
無症状者からの感染はごく稀と出ましたので、扱いとしては、インフルエンザ等と一緒で、症状ある人は家で休みましょう。で良さそうですね!+7
-2
-
2080. 匿名 2020/08/21(金) 00:36:57
>>2061
逆じゃない?
ちゃんと世界の状況やニュース把握している人は自粛すべきところはきちんとして賢く動いてるよ。
コロヒスとか自粛厨なんて闇雲に煽ってる人達は日本のことを真剣に考えていない、それこそ情弱でしょ。
+7
-4
-
2081. 匿名 2020/08/21(金) 00:36:59
>>2071
Nintendoは今後も続くか分からないし、ヤマトもイベントや業務用が減ってるから蓋を開ければ横ばいみたいよ
花王なんかもそうだけど
巣籠もりは一定の期間を過ぎると落ち着くからね+7
-0
-
2082. 匿名 2020/08/21(金) 00:37:04
>>2009
真面目に都の基準で対策して無い飲食店経営者じゃないの?
都がステッカー貼ってる店に抜き打ちチェックしに行くけど、足らないから民間グループや食べログのようなコロナ対策口コミサイトを作るって3日前くらいにニュースで放送してた。+3
-0
-
2083. 匿名 2020/08/21(金) 00:38:14
>>2070
緊急事態宣言解除したとたん
このありさま。
事態は数倍に悪化して、感染者が増えるばっかり
新たな感染者をゼロにしてから言うことだね。+2
-8
-
2084. 匿名 2020/08/21(金) 00:38:44
>>2016
横だけど、
今年の夏休みの旅行先はニュージーランドって決めてたんだよねー
断念したけどいつか行く!+2
-0
-
2085. 匿名 2020/08/21(金) 00:39:10
スウェーデンは異端と言われてるけど+1
-0
-
2086. 匿名 2020/08/21(金) 00:39:22
>>2066
普通に侵略されますよ、c国に。あなたが臓器ぶん捕られる覚悟があるならやればいいんでない?
その前に白いおまんま食べれなくなりますけど。+4
-1
-
2087. 匿名 2020/08/21(金) 00:39:23
>>2081
もしろ今回の決算だけで、任天堂の売り上げが続くと思う人はある意味びっくりお花畑
+4
-0
-
2088. 匿名 2020/08/21(金) 00:39:24
>>2078
わかる。自粛しろって無理強いするのも、自粛せず経済回せって無理強いするのも嫌だし、されるのも嫌だよね。+6
-0
-
2089. 匿名 2020/08/21(金) 00:39:27
>>2071
その発言だと今回の企業の決算を見て言ってないよね?
ニュースで取り上げた一部の報道だけでいってそう+7
-2
-
2090. 匿名 2020/08/21(金) 00:39:50
毎日のコロナ死者は日本は10人。交通事故とほぼ同じだが、毎日マスコミが騒ぐから不安になる。PCR検査を増やしても死者は減らない。不安がいつまでも続くだけ。+4
-2
-
2091. 匿名 2020/08/21(金) 00:39:51
>>2071
賛成+2
-4
-
2092. 匿名 2020/08/21(金) 00:40:33
>>2080
同意。そして賢く動いている人がほとんどだよね。+5
-3
-
2093. 匿名 2020/08/21(金) 00:40:39
>>2081
どんな企業も続くかなんてわかんないよ。
経営がだめなら、倒産。
それが資本主義経済なので。
力の無いところ瞑れる。
それだけだよ。+5
-3
-
2094. 匿名 2020/08/21(金) 00:40:48
>>2071
通販の企業はかなり儲かってるってね。120%売上伸びたからボーナスも増えるってねネットニュースに書いてあった。
ガーデニング関連の商品は例年の2倍売れてるってさ。
+6
-1
-
2095. 匿名 2020/08/21(金) 00:40:57
マスコミはもう救いようが無いですね。
ここの所ずっと新規陽性者より退院者のが多いから 数で煽っても無駄と気付いた。
減ってきたら今度は重傷者数、ベット数の議論。
直接コロナではなく基礎疾患の重篤な人がコロナにかかっただけです。
毎日おかしなネタで煽るのやめてください。
+9
-0
-
2096. 匿名 2020/08/21(金) 00:41:04
>>2080
自分と身内、自分のお世話になるであろう医療従事者しかみてないのはわかる+5
-1
-
2097. 匿名 2020/08/21(金) 00:41:41
>>2071
浅くてビックリ+5
-0
-
2098. 匿名 2020/08/21(金) 00:41:50
>>2061
渋谷勤務のアピール意味不明。
そんな浅はかなコメントして他の渋谷勤務がる民もらい事故なんだけど。+9
-1
-
2099. 匿名 2020/08/21(金) 00:42:58
>>2098
キャバ+1
-1
-
2100. 匿名 2020/08/21(金) 00:43:05
私の知り合いはこんな時でもオリンピックが開催されること夢みてチケットの払い戻ししていません。+1
-1
-
2101. 匿名 2020/08/21(金) 00:43:07
>>2093
でも今回みたいにいきなりサービス業、製造ダメですってなると国も救済出来ないし大変だよ
10年とかかけて需要が減るならどこの企業も次の時代へと転換できるかもしれないけど
さすがに半年でいきなり変わることはできない
そうなると、日本の経済は一気に冷え込むから国民の生活にも直結するよ
増税待ったなし+8
-1
-
2102. 匿名 2020/08/21(金) 00:43:31
>>2086
チャイナっていつになったらバブル崩壊するの?+0
-0
-
2103. 匿名 2020/08/21(金) 00:44:17
自粛が経済災害の原因なんだから、自粛をやめることが最大の経済対策。できもしない封じ込めを主張しても誰も相手にしない。+10
-3
-
2104. 匿名 2020/08/21(金) 00:44:34
>>2094
儲かってるところは儲かってるよね
巣籠もり需要で食品メーカーも儲かってるところもある+6
-2
-
2105. 匿名 2020/08/21(金) 00:44:57
>>2071
ヤマトはアマゾンの契約で不利になってるんじゃなかった?
佐川急便は凄いよ株価が去年の今頃に比べて2倍近くになってた。+2
-0
-
2106. 匿名 2020/08/21(金) 00:45:03
>>2063
ヤバイね+0
-0
-
2107. 匿名 2020/08/21(金) 00:45:14
>>2094
部門によっては下がってるよ
売れてるのは日用品や住宅に関係するもの
売上としては横ばいくらいかもね
一つ一つの単価が減るから+5
-1
-
2108. 匿名 2020/08/21(金) 00:45:17
>>2061
第一、コロナに感染した時点で、経済がー
っつても、終わってるじゃん。
病院に金かかって、もちろん店なんて無理。
コロナをだした店なんて、石投げられる
だけでしょ。
一番大事なのは、コロナに感染しない
と、いうこと。
だから感染を広める感染者はどんな理由が
有ろうと、意味嫌われる。
感染者=感染源だしね
+7
-6
-
2109. 匿名 2020/08/21(金) 00:45:21
>>1965
わかる!
私、基礎疾患もちなんだけど、病気のつらさ痛いほどわかる。
だから、コロナ冷静にみて、そんなに怖くない。
高齢者基礎疾患ありは注意が必要だけど。それは、どんな病気も同じ。
今までのインフルエンザなどと同じ感染症対策しかしてません。+14
-4
-
2110. 匿名 2020/08/21(金) 00:45:37
>>2024
なぜマイナスなのかわからないなら、リアルで周囲に聞きまくってみればいいと思う。きっと答えてくれるよ。ただし、結果は自己責任でヨロシク。+2
-4
-
2111. 匿名 2020/08/21(金) 00:45:54
>>2102
今、全世界で完膚なきまでにしたら終わります。
説明すると長くなるんでやめますが、めんどくさいですよねー。+1
-1
-
2112. 匿名 2020/08/21(金) 00:45:56
>>2099
あー、キャバ勤務か。
渋谷はキャバクラとさえ呼べないような店ばかりだけどね。+4
-3
-
2113. 匿名 2020/08/21(金) 00:46:16
>>2063
東京も中年層の感染者増えてるからこの先どうなるかは分からんけど、大阪は相変わらず多いわね+5
-0
-
2114. 匿名 2020/08/21(金) 00:46:31
政府も感染源数 500超えた時点で
緊急事態宣言出すとか。なにか対策を打たないと
どうにも収まりつかないよ。+2
-5
-
2115. 匿名 2020/08/21(金) 00:47:32
>>2104
食品は冷凍食品はそうだろうね
反対に飲料は下がってる
飲食店やイベントなどの業務用が減ってるし、皆が外出しないからペットボトルも売上が減る+1
-0
-
2116. 匿名 2020/08/21(金) 00:48:06
あの高いクルーズ船の乗客も殆ど中高年以上でしたからね。年寄りが経済に貢献してる事は間違いないと思います。年寄りが自粛すればシルバー産業、病院の破綻はかなり出るはずです。
若者は行動力があってもお金がないから経済を回せない+6
-0
-
2117. 匿名 2020/08/21(金) 00:48:06
>>2111
早くバブル崩壊して、かつての日本以上に不況になって共産党も崩壊すればいいのにね+3
-0
-
2118. 匿名 2020/08/21(金) 00:48:49
>>2052 都市伝説か。くだらねー。
+0
-0
-
2119. 匿名 2020/08/21(金) 00:48:49
>>2108
ドヤってるけど、じゃあどうすりゃいいの?w
コロナ感染なんてロシアンルーレットよ?
夜の街にも行かず、予防しても感染してる人もいるけどこれはどう説明できるの?+4
-0
-
2120. 匿名 2020/08/21(金) 00:48:59
>>2061
渋谷勤務の人の世界情報ってどんななの?+4
-1
-
2121. 匿名 2020/08/21(金) 00:49:34
自粛したい人、したくない人、色々いると思うけどとりあえず日本企業潰さないようにここは一致団結して各自できるだけ消費するのはどう?+9
-3
-
2122. 匿名 2020/08/21(金) 00:49:37
>>743
観光客の方?
+1
-0
-
2123. 匿名 2020/08/21(金) 00:50:12
>>2084
ヨーロッパに駐在してた親も今までで1番良かったのはニュージーって言ってたよ
私はカナダが良かったけど
はやくいけるといいよね+0
-0
-
2124. 匿名 2020/08/21(金) 00:50:35
>>2112
勝手に判断すんな能単バカ
それとも50すぎたおばたんですか?+2
-3
-
2125. 匿名 2020/08/21(金) 00:50:48
>>64
仕事で書き込みしてる方々はともかく、感染者数に一喜一憂してるバカは永遠に怯えなきゃいけないだろうね+8
-0
-
2126. 匿名 2020/08/21(金) 00:50:57
>>2080
だよねー
リアルでは
お盆の帰省は諦めたよ、家の庭で家族でBBQしたよ
みたいな人が多数派
コロナは忘れて経済まわそーはむしろがるちゃんでしか見ないタイプ
+11
-3
-
2127. 匿名 2020/08/21(金) 00:51:12
>>2103
クラスター対策の専門家はゼロは無理と言ってる
リスクをどれだけ許容しながら、また用心もしながら活動するかが肝だと
旅行などは自粛もし、用心しながら仕事や生活まわしてる人もゼロが目標とは思ってない+5
-0
-
2128. 匿名 2020/08/21(金) 00:51:24
>>2120
自分で調べろよ汚い面+0
-7
-
2129. 匿名 2020/08/21(金) 00:52:11
>>2104
儲かってるとこは儲かってても日本のGDPの6割を占める個人消費が落ちてる。
お金が回ってない
【速報】4~6月期GDP、戦後最悪の落ち込み(TBS系(JNN)) - Yahoo!ニュースnews.yahoo.co.jpことし4月から6月までのGDP=国内総生産は年率換算でマイナス27.8%と新型コロナウイルスの影響で過去最悪となりました。 日本経済は戦後最悪の状態にあり、まさに正念場に立たされています。
+5
-0
-
2130. 匿名 2020/08/21(金) 00:52:48
こうゆう論争が、二次災害なんだよね。落ちついて出来る事は、マスクに手洗い三密を避けるとかよね。それしか今は、出来ないね。守らない人、意識してもらいたいな。。+4
-0
-
2131. 匿名 2020/08/21(金) 00:52:58
>>2120
なんか、キャバだとかたくさん書いてるようだけど意外と渋谷ってIT系やベンチャー多いよ
だから結構成果主義の会社も多いかと
今だと、テレワーク切り替わった所も多いんじゃないかな?
あとGoogleもあるよ+5
-2
-
2132. 匿名 2020/08/21(金) 00:53:17
マスコミってあれでしょ。
「今はみんなで我慢のとき」を意図的にずっと続けたがる人たちでしょ。
「2週間後には~」→「秋冬には~」
→来年になったら「今年はウイルスが変異して昨年よりも~」
でしょ。
実際にコロナがどのくらい危険かは別として、少なくともマスコミは信用に値しない。+3
-0
-
2133. 匿名 2020/08/21(金) 00:53:20
>>2107
通販事業は全体的に伸びてるよ
>>通信販売業界を代表する業界団体である公益社団法人日本通信販売協会(粟野光章会長、正会員433社)では、協会の理事社・監事社を中心とする会員企業計126社を対象として2020年6月度の売上高調査を実施しました。
8月3日にまとまった調査概要によると、2020年6月度の総売上高(126社)は1,269億円となり、前年同月比でみると+10.8%と増加しました。
伸び率を商品別でみると、「衣料品」は前年同月比+14.6%、「家庭用品」は+32.1%、以下「雑貨」+1.3%、「食料品」+21.8%、「通信教育・サービス」+29.8%となりました。
公益社団法人 日本通信販売協会【JADMA(ジャドマ)】www.jadma.or.jp公益社団法人 日本通信販売協会【JADMA(ジャドマ)】消費者のみなさま事業者のみなさまサイトご利用メニューサイトのご利用についてサイトマップEnglishサイト内検索タイトル入会案内通販協会について活動スケジュールJADMAマークについて統計・出版会員社一覧キー...
+2
-0
-
2134. 匿名 2020/08/21(金) 00:53:31
>>2099
今お客さん入ってます?+0
-0
-
2135. 匿名 2020/08/21(金) 00:53:56
>>1952
嫌なら出て行けばよくない?まぁ、ニュージーランドもこられるの凄く嫌だろうけど。+1
-0
-
2136. 匿名 2020/08/21(金) 00:54:14
>>2124
下品な言葉がやっぱりキャバだわ+6
-1
-
2137. 匿名 2020/08/21(金) 00:54:18
>>2127
それ、私も何度も何度も何度も言ってきたんだけど聞かないんだよ
ここの経済ガーは
ゼロにならないなら自粛は無駄だーの一点張り
たぶん馬鹿なんだと思うの
+8
-3
-
2138. 匿名 2020/08/21(金) 00:54:19
>>2103
自粛してもしなくても変わらなかったね。
ウイルスは変異したみたいだけど。+0
-4
-
2139. 匿名 2020/08/21(金) 00:54:43
日本が経済停滞
↓
個人商店などの体力のない事業を安く買える
↓
元の価格が暴落する前に買い叩きたい
もっと経済を自粛させたい
↓
行政やメディアに自粛を促させる
↓
日本の失業や経済の破綻が増える
↓
買い叩く+3
-1
-
2140. 匿名 2020/08/21(金) 00:54:49
>>2131
私も渋谷ってITのイメージある
サイバーエージェントとか
キャバってなんだw+3
-2
-
2141. 匿名 2020/08/21(金) 00:55:06
>>2137
横だけど、あなたはどうしたらいいと思うのか聞いてみたい+4
-1
-
2142. 匿名 2020/08/21(金) 00:55:12
「マスク転売規制、29日解除へ」
転売をOKにする政府ってマジでなんなのって思うわ+1
-0
-
2143. 匿名 2020/08/21(金) 00:55:13
>>2137
全文同意です+4
-2
-
2144. 匿名 2020/08/21(金) 00:55:43
>>2133
生活に直結するものが多いね
娯楽関係やスポーツ関係は売れなくなったんだろうな+3
-0
-
2145. 匿名 2020/08/21(金) 00:55:43
自粛強要はしないけど、室内でマスクはつけろ!と思う。そんな私はコロヒスですか?+0
-1
-
2146. 匿名 2020/08/21(金) 00:56:05
>>2124
否定はしないの?+1
-0
-
2147. 匿名 2020/08/21(金) 00:56:50
>>2137
何がゴール?+0
-0
-
2148. 匿名 2020/08/21(金) 00:57:21
>>2145
十二分にコロヒスです+0
-1
-
2149. 匿名 2020/08/21(金) 00:57:34
>>2135
ニュージーに住むならこれから働いて食べて行かないといけないんだから日本より大変だわな。
ニュージーこれから大変だわ、こりゃ。
トレーダーなら勝手どこへでも。+2
-1
-
2150. 匿名 2020/08/21(金) 00:57:48
>>2140
単純にキャバクラじゃない?
夜だし+2
-0
-
2151. 匿名 2020/08/21(金) 00:57:49
>>2119
運が悪かったね
努力しても、結果が駄目では無自覚と同じ。
感染者である以上、危険人物。
+1
-3
-
2152. 匿名 2020/08/21(金) 00:57:49
>>2137
果敢に説明しては玉砕している人をたまにみるけど、あなたもその一人だったのね。お疲れ様です。+4
-2
-
2153. 匿名 2020/08/21(金) 00:57:53
>>2126
横だけどわかる。
周りは仕事とプライベートは家族だけで行動してる
帰省はしてない人ばかり
ガルちゃんはやっぱり変わってるよね+6
-3
-
2154. 匿名 2020/08/21(金) 00:58:53
>>2150
そういうことを聞いてるんじゃない気がする…+1
-0
-
2155. 匿名 2020/08/21(金) 00:59:21
ここでの書き込みを見ていてもやはり感染者がゼロになるまで経済は回せない。もう手遅れ。+0
-3
-
2156. 匿名 2020/08/21(金) 01:00:02
>>2121
賛成!っていうか、自粛派だけどもうやってるよー。県内で動き回ってる!+5
-0
-
2157. 匿名 2020/08/21(金) 01:00:18
>>2137
愛知県なんて、ずっとゼロ続けてきて
東京から感染で感染拡大させたしね。
危機感の無い東京が、経済がーって
日本中にコロナをばら蒔いた。+5
-7
-
2158. 匿名 2020/08/21(金) 01:00:20
遊ぶけど実家には帰らないタイプ。
外食ばかりだわ。
高齢者にうつしたら重症化するかもだし。+4
-1
-
2159. 匿名 2020/08/21(金) 01:00:20
>>2150
渋谷にキャバのイメージが無かったのよ
みんなバカにしすぎw
そんな私は汐留OL+2
-1
-
2160. 匿名 2020/08/21(金) 01:00:34
>>2155
その煽りもう飽きたー+5
-0
-
2161. 匿名 2020/08/21(金) 01:00:52
>>2155
やっぱり無職だよね?+5
-0
-
2162. 匿名 2020/08/21(金) 01:01:05
>>1917
むしろ私は土人達の入国規制緩和による治安の悪化の方が怖いですけどね。
それが日本人に伝染して、満員電車がまた通常化したらケンカも絶えなそう。+3
-0
-
2163. 匿名 2020/08/21(金) 01:01:11
>>2052
MI6の諜報部員ならまだしも、ガル民の陰謀論ねぇ
おママゴトだね。+0
-0
-
2164. 匿名 2020/08/21(金) 01:02:09
>>2156
いや動き回るのは予防意識低すぎ。+2
-5
-
2165. 匿名 2020/08/21(金) 01:02:26
>>2159
キャバ、風俗多いよ。
オフィスと近いとこに。
itは駅から遠いね。+2
-0
-
2166. 匿名 2020/08/21(金) 01:02:52
「東京を封鎖しろ」なぜ日本人はこれほどコロナを恐れてしまうのか 医師「コロナより大事なことがある」 | PRESIDENT Online(プレジデントオンライン)president.jp恐怖は、自分の生命の危機がせまっているときに強く感じる感情です。心配事は、未来に終わりのない不安をいだかせます。恐怖も不安も、人間の生存にとって必須で根源的な感情ですが、過剰になってしまうと焦って考…
+3
-0
-
2167. 匿名 2020/08/21(金) 01:03:55
>>2053
もう海外旅行とかまずムリでしょ。てか海外との経済再会したら感染者が増えるどころかウィルスが変異するか日本のウィルスがアメリカや欧米並に強くなると思う。+5
-2
-
2168. 匿名 2020/08/21(金) 01:04:24
>>2165
ヒカリエ側は多いよ
+1
-0
-
2169. 匿名 2020/08/21(金) 01:04:36
無職、テレワーク自粛民は自粛を強要しないで。
勝手にしてていいから。
無職に専業入れてごめんやけど。+3
-3
-
2170. 匿名 2020/08/21(金) 01:04:40
>>2128
キャバさん言葉使いには気をつけてよー
渋谷勤務の恥だからさ+3
-0
-
2171. 匿名 2020/08/21(金) 01:05:02
>>98
第一波の時と、重症者の基準が違うのも一因です。
現在東京ではICU入りと気管挿入は重症者としてカウントしていません。+0
-0
-
2172. 匿名 2020/08/21(金) 01:06:09
>>2168
そこよりマークシティ側じゃない?飲み屋
道玄坂路地いけば風俗系+3
-0
-
2173. 匿名 2020/08/21(金) 01:06:22
自粛派が自分以上の自粛派に叩かれ、お互いストレス。+3
-2
-
2174. 匿名 2020/08/21(金) 01:06:48
>>2167
日本で流行ってんのはとっくに欧州型です+1
-2
-
2175. 匿名 2020/08/21(金) 01:07:49
+1
-5
-
2176. 匿名 2020/08/21(金) 01:07:56
>>2124
わー本当に頭悪いんだね。
能単って、、それをいうなら単能だよ!
無理してコメント投稿しなきゃいいのに。
+2
-0
-
2177. 匿名 2020/08/21(金) 01:07:58
>>2101
ホントにそう。アビガンで脚光を浴び、業績を上げている
富士フィルムだって、一昔前はカメラのフィルム製造してたから
大幅な業態転換したもんね。
予告なしにいきなり、業態転換を半年以内にはちょっと厳しい条件だね。
+2
-0
-
2178. 匿名 2020/08/21(金) 01:08:08
>>2103
石田純一と似たような行動をずっとしてきた?
コロナヒスと言ってるトピでは2月でも旅行やカラオケ、外食等生活は全く変えてませんって書き込みに大量にプラスついてたけど?+0
-0
-
2179. 匿名 2020/08/21(金) 01:08:57
>>2169
強要してないよー。だからコロナはただの風邪、自粛やめて経済回せって強要しないでねー。+8
-1
-
2180. 匿名 2020/08/21(金) 01:09:11
>>2141
横
返信のリンク辿ったらわかるけど+1
-0
-
2181. 匿名 2020/08/21(金) 01:09:31
パンデミックの終わり方は2通り。
1つは医学的な終息で、罹患率と死亡率が大きく減少して終わる。
もう1つは社会的な終息で、病気に対する恐怖心が薄れてきて終わる。
「『いつ終わるんだろう』と人々が言う場合、それは社会的な終息を指している」と、ジョンズ・ホプキンス大学の医学史学者、ジェレミー・グリーンは言う。
つまり、病気を抑え込むことによって終わりが訪れるのではなく、人々がパニック状態に疲れて、病気とともに生きるようになることによっても、パンデミックは終わるということ。
コロナ怖い怖いの人たち、はよパニック終わろうや+1
-4
-
2182. 匿名 2020/08/21(金) 01:09:32
>>2126
わたしの周りもまさにそんな感じ。
コロナは風邪だしコロヒスうざい、みたいなのはがるちゃんだけだよね。
工作員かね?+8
-2
-
2183. 匿名 2020/08/21(金) 01:10:01
+0
-0
-
2184. 匿名 2020/08/21(金) 01:10:17
>>2179
純粋な質問良い?
元々インドアな人ですか+1
-1
-
2185. 匿名 2020/08/21(金) 01:10:46
飲み歩きじいさんみたいな生活してるガル民なんてあんまりいないだろ。
普通に仕事行き、手洗いうがいマスク、たまにの外食みたいな人が多いんじゃない?夜のガル民は。
昼間は人種が違うね。+2
-0
-
2186. 匿名 2020/08/21(金) 01:12:19
>>2175
ウイルスはなによりも小さいです
本当に怖いなら
本当に相手にうつしたくないなら
ガスマスクを付けてください
無理ならそれは、他人の目が怖いからつけてるからです![東京都で新たに339人の感染確認 5日ぶり300人超 重症者は4人増え36人]()
+1
-1
-
2187. 匿名 2020/08/21(金) 01:12:40
>>2178
石田純一が何してたか知らないけど、外食も旅行も普通ペースで行ってる+1
-1
-
2188. 匿名 2020/08/21(金) 01:12:40
>>2179
それ強要じゃないやん。笑
信じる信じない、同調しないするのレベル。
自粛民は何で人混み行くの!?頭おかしいってキレてくるから。笑+2
-4
-
2189. 匿名 2020/08/21(金) 01:13:26
>>2175
こんな不衛生なマスク付けて近寄らないでください![東京都で新たに339人の感染確認 5日ぶり300人超 重症者は4人増え36人]()
+3
-0
-
2190. 匿名 2020/08/21(金) 01:13:35
会社でマスクしてたんだけど何かの弾みで咳込んだ。
結果、上司から居残り説教だよ。
「こんな時期だからできるだけ咳をしないように。周りを不快にさせる事はするな」+0
-0
-
2191. 匿名 2020/08/21(金) 01:13:45
>>2169
夫テレワーク私主婦、全く強要しないよー
休みは普通に対策しながら出かけてる+4
-0
-
2192. 匿名 2020/08/21(金) 01:14:03
>>2184
気まずくなる質問やめてください+1
-0
-
2193. 匿名 2020/08/21(金) 01:14:10
>>2180
自粛をやめることか+0
-0
-
2194. 匿名 2020/08/21(金) 01:14:29
>>2177
1月の春節あたりで中国人が大量に入ってきて騒ぎになってた時に真剣に事業形態考えてコロナでも対応するようにすぐに変更を実行した企業は今後も上手く行くと思う。
TVに出てた東京の外国人観光客向けの旅館は4月半ばまで楽天的に考えて、何も対策とかして無かったけど更に国に大金を借りてたし。+0
-0
-
2195. 匿名 2020/08/21(金) 01:14:32
>>2179
ほんとそれ!
マスクしてこまめな手洗い心がけて通勤してますってコメントしただけでコロナ脳、自粛をいつまで続けるつもりですか?的なコメントもらったわ+6
-2
-
2196. 匿名 2020/08/21(金) 01:14:32
>>2172
あのラブホ街のあたりの話?
20代前半の頃は行ったわ
もはや縁ないからそんなことも忘れてたけど+2
-0
-
2197. 匿名 2020/08/21(金) 01:14:54
>>2124
能単、、?
精一杯の悪口が間違ってるって誰か教えてあげてください。
まずは日本語のお勉強しましょうね。
話はそれから。+1
-0
-
2198. 匿名 2020/08/21(金) 01:15:01
>>2126
レジャー楽しむ派も用心しながらって人しかいない
コロナ忘れて動き回ったらかえって経済は停滞しちゃうもの+3
-3
-
2199. 匿名 2020/08/21(金) 01:15:25
>>2191
それでよしだね!
それが普通
こんなとこで人を変えようとしてる人はおかしい+6
-0
-
2200. 匿名 2020/08/21(金) 01:16:04
自粛厨さん、マスク厨さん、後遺症厨の皆さんへ
あなた達は今、集団心理状況下の病理的な精神状態に陥ってます
大丈夫ですよ🙆♀️✨
徐々に治しましょうね
センセーショナルな意見しか言えない自己保身型のメディアの情報だけを見ず、色んな人の意見を見てください
目が覚めたら、現実の世界に戻ってらっしゃい(о´∀`о)!+4
-6
-
2201. 匿名 2020/08/21(金) 01:16:30
>>2188
自粛やめて経済回せって十分に強要してるじゃん。自覚無かったのもしかして?+7
-1
-
2202. 匿名 2020/08/21(金) 01:17:37
>>2199
あんまり神経質になりすぎても…だしね。
そして無職と言われても平気なタイプの穏健派です。w+6
-0
-
2203. 匿名 2020/08/21(金) 01:17:42
「用心していても感染した人はみんな同罪」です。
本人が予防していたと言っても周りは信じません。
+1
-7
-
2204. 匿名 2020/08/21(金) 01:17:59
>>2195
横
それは災難ね。
でもそれが普通だよ。
外食信じられないとか買い物しか行かないよ普通みたいなこと言う人が強要してくる。+2
-2
-
2205. 匿名 2020/08/21(金) 01:18:07
>>2140
渋谷シリコンバレー計画なんて言って頑張ってるけど、みんなが言うようにキャバ風俗多くて基本は汚い街だよ。
渋谷区生まれより+5
-0
-
2206. 匿名 2020/08/21(金) 01:18:21
>>2184
違うよー。動き回る場所を選ぶようになったのよ。
+2
-0
-
2207. 匿名 2020/08/21(金) 01:19:12
何人が重症化したのですか?
それは本当にコロナが原因ですか?
それと、最終的に治ってしまう症状は後遺症ではありません。
「命を大切に」と言いますが生活や文化、経済を大切にしなければ他人の命を大切にすることは出来ません。
お金がなければ日本では人は死ぬのです。
+1
-4
-
2208. 匿名 2020/08/21(金) 01:19:34
>>2202
ここだと無職とか言うと怒られるから。
ただ分けるの面倒だから仕事をしてない人を無職と言ってまとめただけなのに。+1
-2
-
2209. 匿名 2020/08/21(金) 01:20:10
>>2144
体幹を鍛える系のインドア用のフィットネスの器具は売上4倍になったのをニュースで放送してたの見たよ。
インドアで楽しめるかどうかが売れ行きに直結してる。+1
-0
-
2210. 匿名 2020/08/21(金) 01:21:18
>>2201
してないけど。笑
ご自由にの精神だもん。+3
-3
-
2211. 匿名 2020/08/21(金) 01:22:10
>>2181
パニックになってる人なんかもういないよー
仕事しながら冷静に自粛してる人はたくさんいるのよ
仕事が大切だから予防してるんだよね
ただの風邪ですら感染はしたくないの
体調万全で仕事したいじゃん+9
-0
-
2212. 匿名 2020/08/21(金) 01:22:30
>>2078
ケイザイガーさん達、少し前までは若い人たちでまわせばいいって言ってたような…
結局お金持ってるのが50代以上とかで、やっぱり年寄りも自粛すんなってことなんだろうか。
なかなかの身勝手だわ。+7
-3
-
2213. 匿名 2020/08/21(金) 01:23:03
>>2207
>それと、最終的に治ってしまう症状は後遺症ではありません。
コロナの後遺症が完全に治るって研究報告まだ見てないけど、どれ?
ソースよろしく+0
-0
-
2214. 匿名 2020/08/21(金) 01:23:21
間違った事が正しい事と通る世の中で、
立ち上がるのは義務だと考えます。
いくら罵倒されようが私は言い続けます。
コロナはただの風邪である。
亡くなった方は寿命である。と
あなたの身内が亡くなったら?どうするんだって
ドがつく脳足りんは発言する権利を剥奪したい
すべてはあなたの自己保身に徹し、感情論で話にならない+6
-8
-
2215. 匿名 2020/08/21(金) 01:23:47
クラブ(踊るほう)とか密になってガンガンやってるよ。若者はそれでいいと思うわ
+2
-2
-
2216. 匿名 2020/08/21(金) 01:23:49
>>2210
日本語、もっと勉強した方がいいよ…。+1
-2
-
2217. 匿名 2020/08/21(金) 01:23:50
>>2208
たまにいきなり怒り出す人いるよね。
それはこっち側から見てても不思議だから気にしないで。
自粛でイライラしてるのかもね。+7
-1
-
2218. 匿名 2020/08/21(金) 01:24:28
>>2175![東京都で新たに339人の感染確認 5日ぶり300人超 重症者は4人増え36人]()
+0
-5
-
2219. 匿名 2020/08/21(金) 01:24:53
>>2212
ケイザイガー寄りだけど自粛してもらって結構
ただ文句は言わないでねって感じ+5
-4
-
2220. 匿名 2020/08/21(金) 01:24:55
>>2207
生活や文化、経済を大切にしながら自粛しつつ毎日出勤してますの+4
-0
-
2221. 匿名 2020/08/21(金) 01:25:36
>>2216
高卒乙ww+2
-1
-
2222. 匿名 2020/08/21(金) 01:25:47
>>2047
ニュージーランドは今真冬に70人で済んだんでしょ?
2月の日本なら感染者何人くらいを予測してる?+0
-0
-
2223. 匿名 2020/08/21(金) 01:25:57
ここで飯テロ(小声)![東京都で新たに339人の感染確認 5日ぶり300人超 重症者は4人増え36人]()
+7
-0
-
2224. 匿名 2020/08/21(金) 01:26:14
>>2213
そもそも後遺症の定義の説明だよ
一生涯残る症状を後遺症っていうの。足を骨折して歩行困難になってもリハビリをして症状が残らないならば後遺症とは言わない。
症状が収まってないことを後遺症とは呼ばないってことだよ
+0
-1
-
2225. 匿名 2020/08/21(金) 01:26:30
>>2210
わー…+1
-1
-
2226. 匿名 2020/08/21(金) 01:26:35
>>2216
経済回せは私言ってないもん。笑
日本語勉強ってなんですの?笑+3
-3
-
2227. 匿名 2020/08/21(金) 01:27:34
転売禁止解除って、マスクアルコール増産して余ってるから転売してくれって声が中国からあったの?
禁止して困るのなんて転売業者くらいでしょ?解除する意味が真剣に分からない。コロナじゃなくても衛生必需品は転売禁止で良いよ。+2
-0
-
2228. 匿名 2020/08/21(金) 01:27:42
>>2222
日本の人口比にすると1800人だったとか
そりゃあニュージーもパニックになるよね+0
-0
-
2229. 匿名 2020/08/21(金) 01:27:45
>>2099
+0
-0
-
2230. 匿名 2020/08/21(金) 01:27:46
皆イライラムラムラしないで!+2
-0
-
2231. 匿名 2020/08/21(金) 01:28:27
風俗で働いてるけどお客さんくるよ
+1
-1
-
2232. 匿名 2020/08/21(金) 01:28:46
>>2141
具体的には難しいけど、方向性は経済と感染予防が均衡する点を探るべきだと思うよ
何をどう言ったって感染拡大したら、必ず国や自治体からストップがかかる
国や自治体は高齢者や基礎疾患がある人や医療体制を守らないといけないからね
感染拡大すると経済活動に国や自治体から待ったがかかって結局経済停滞
感染拡大を無視して経済まわそーは現実として無理な話
一方で、国や自治体は国や地域の経済も守らないといけない
経済無視して感染予防しようも現実として無理な話
答えを出すのは難しいけど、国や自治体は経済と感染予防のどちらもやらないといけないので、少なくとも片方をゼロにしようなんて訴えは無意味なんだよ+1
-1
-
2233. 匿名 2020/08/21(金) 01:28:48
>>2219
自粛したきゃすればいいし、ケイザイガーは普段通りにすごしたらいいじゃんね?+5
-0
-
2234. 匿名 2020/08/21(金) 01:28:55
コロナはただの風邪!自粛するやつは無知のバカ!イベントやって経済回す俺らはそういう愚民とは違う!と煽ってホリエモン祭のチケット売ってたホリエモンだけど
祭の開催要項の中にコソッと「感染症については責任は負いません」の文言を入れてたのは何故?
ただの風邪ならそんな予防線要らないよね
「ただの風邪」って言って自分達の利益のために都合いい方に持っていきたがる人達は、それで感染拡大しても責任なんか取らないよ+6
-0
-
2235. 匿名 2020/08/21(金) 01:29:10
>>2144
任天堂かなり利益出してたよ+0
-0
-
2236. 匿名 2020/08/21(金) 01:29:55
>>2036
いちいちうるさい+2
-1
-
2237. 匿名 2020/08/21(金) 01:29:57
>>2235
あつもりかな〜+1
-0
-
2238. 匿名 2020/08/21(金) 01:29:58
未だに自粛とか経済を回すとかいう言葉を使ってる人がいることに引くわ
リアルな世界で生きてる人は仕事を止める訳にはいかないし、感染予防も意識してる
足の引っ張り合いでなく、この時代をどう生きてくかを考えながら前を向いてる人が大半だと思うんですけど
+2
-0
-
2239. 匿名 2020/08/21(金) 01:30:18
>>2224
横だけど、「後遺症ですねーいずれ治ることがほとんどですが100%とはいえません」がうちのドクターの決まり文句
コロのことじゃないよ
一般的に口にされる後遺症ね+0
-0
-
2240. 匿名 2020/08/21(金) 01:30:28
>>2233
もちろんそうします!+3
-0
-
2241. 匿名 2020/08/21(金) 01:30:31
>>2234
指定感染症に指定されてるから鬱陶しいんでしょ
行政が外せば問題ないんだけどね
だって風邪だもん+3
-2
-
2242. 匿名 2020/08/21(金) 01:30:31
>>2225
自粛すればいいし、経済回せの人はいつもみたくすごしたらいいじゃん。何か間違えてる?+2
-1
-
2243. 匿名 2020/08/21(金) 01:30:39
>>79
はいはい2週間後が心配+1
-0
-
2244. 匿名 2020/08/21(金) 01:31:06
ラブホがほぼ満室だった。緊急事態宣言あたりはガラガラだったのに。良い傾向!+3
-4
-
2245. 匿名 2020/08/21(金) 01:31:13
>>2242
つっこまれてるのは日本語理解力の話しと思うw+0
-0
-
2246. 匿名 2020/08/21(金) 01:31:21
>>2240
そうだよね?私もそうしてる!
なんか強要したりキレてる人が多い。。+1
-0
-
2247. 匿名 2020/08/21(金) 01:31:22
>>90
捏造だ隠してるって毎日唾飛ばしまくってギャンギャン騒いでたよね+1
-0
-
2248. 匿名 2020/08/21(金) 01:31:32
>>2230
電池交換しなきゃ(´・ω・`)+0
-0
-
2249. 匿名 2020/08/21(金) 01:31:36
>>2226
「コロナはただの風邪、自粛やめて経済回せって強要しないでねー」に対して「それ強要じゃないやん」って発言したのあなたじゃないの?アンカ辿るとそうなるけど。+1
-0
-
2250. 匿名 2020/08/21(金) 01:31:53
>>1949
自粛しても通販やオンラインサービスをしまくって家計の支出変わらないわ。+0
-1
-
2251. 匿名 2020/08/21(金) 01:32:39
この時間って工作員ばかりだね。+2
-1
-
2252. 匿名 2020/08/21(金) 01:32:42
>>2224
だから、コロナから回復した後も味覚嗅覚異常や微熱やその他の症状がずっと治らない人達が多数報告されてるでしょ?
その症状が完全に治ったという報告見せて
シンプルな話でしょ+4
-0
-
2253. 匿名 2020/08/21(金) 01:32:53
>>2245
私はわかりました。日本語うんぬんはどこのあたりですか?全部読んでないけど。+3
-0
-
2254. 匿名 2020/08/21(金) 01:32:56
>>2244
あの頃は異常過ぎたね+1
-2
-
2255. 匿名 2020/08/21(金) 01:33:44
>>2251
何の?+0
-0
-
2256. 匿名 2020/08/21(金) 01:34:25
>>2223
肉食べたい![東京都で新たに339人の感染確認 5日ぶり300人超 重症者は4人増え36人]()
+7
-1
-
2257. 匿名 2020/08/21(金) 01:34:56
>>2217
そうだと思う。
あと、は?とかくだらないひとことコメントとか日本人?とか言う人暇だよなぁて。
まじで何でキレてるかわからないw+3
-0
-
2258. 匿名 2020/08/21(金) 01:34:58
>>2246
そうそう
別にこっちは強要もしてないし働いてお金使って生活してるだけだし
まだまだ若いから私たちが動かしていかなきゃね+2
-0
-
2259. 匿名 2020/08/21(金) 01:35:04
マスク転売規制 29日解除へ - Yahoo!ニュースnews.yahoo.co.jp新型コロナの感染拡大により、転売規制されているマスクや消毒用アルコール製品について、内閣府の消費者委員会は20日、規制の解除を妥当とする答申を出した。来週閣議決定され、29日から規制が解除される予定。
これだけ感染者が増えている時にマスク転売解除するとか、この国おかしいよ+9
-0
-
2260. 匿名 2020/08/21(金) 01:35:16
>>2234
コロナは風邪のクラスターイベントに参加してた人で飲食経営者の夫婦いたけど、残りはどんな職業なんだろう。+3
-0
-
2261. 匿名 2020/08/21(金) 01:35:18
>>2215
若い子がは何ヵ月もおうちじかんとか無理だよね+1
-1
-
2262. 匿名 2020/08/21(金) 01:35:31
>>40
やだ!+1
-1
-
2263. 匿名 2020/08/21(金) 01:35:55
>>2256
死刑を宣告します+1
-0
-
2264. 匿名 2020/08/21(金) 01:36:00
>>2216
強要してないよ、ってことなんじゃない?+2
-0
-
2265. 匿名 2020/08/21(金) 01:36:21
夜のニュース見たかな
普通に疑問なんだけど
東京の夜の街
シャンパンタワーして
『ウィーーー』お大勢で騒いでた人達は
何の仕事してるんだろう?+4
-0
-
2266. 匿名 2020/08/21(金) 01:37:11
>>2217
経済回せの人もイラついてるよ
どうしてなのかはなんとなくわかるけど+6
-0
-
2267. 匿名 2020/08/21(金) 01:37:36
>>2215
水着イベントとかやってる。海閉めたぶん、そっちに流れてるね~+0
-2
-
2268. 匿名 2020/08/21(金) 01:37:46
>>2251
がるちゃんはいつもそうだよね+2
-1
-
2269. 匿名 2020/08/21(金) 01:38:06
>>2259
政府が転売ヤーを助けるか、どこかかから金貰ったのか?
転売ヤー助けてどうするんだか、そんなに市場を荒らしたいのか?
国内を混乱に陥れてどうするんだ、やってることがめちゃくちゃもいいとこ
ほんとあり得ないことをする+3
-0
-
2270. 匿名 2020/08/21(金) 01:38:24
>>2266
働く人ディスか?w+2
-2
-
2271. 匿名 2020/08/21(金) 01:38:50
>>2244
名古屋だけど満室に近かったわ+2
-0
-
2272. 匿名 2020/08/21(金) 01:39:39
>>2259
コロナ関係なく永遠に転売禁止で良いのに+8
-0
-
2273. 匿名 2020/08/21(金) 01:39:47
>>2217
自粛でイラつくとか意味わからない
私は自粛してても妬みすらしないもん
自分の選んだことだし+6
-0
-
2274. 匿名 2020/08/21(金) 01:40:07
>>2203
コロナ患者が『マスクが嫌』とノーマスク
医療用マスクしていたのに感染した看護師さんいたのに?+2
-0
-
2275. 匿名 2020/08/21(金) 01:40:14
>>2249
横から入るのってガルじゃ普通だよね。
だれかれかまわずキレないほうがいいよ。+1
-1
-
2276. 匿名 2020/08/21(金) 01:40:43
>>2257
あるあるだね〜w
ネットだし色んな人いるから仕方ないんだけどさ+3
-0
-
2277. 匿名 2020/08/21(金) 01:41:18
>>2153
そもそも経済回そう!って言うほどお金ある人どんだけいるの?って感じ。
服買わない代わりにマスクやらアルコールで使う分増えたし、旅行なんてそもそも年1くらいしかしないし、帰省しなかった分外食しまくりで使ってるお金コロナ前とプラマイゼロだわ。
+4
-0
-
2278. 匿名 2020/08/21(金) 01:41:24
京都がまったく検査してない、感染者絶対もっといる!と言ってますがどうだろう?+2
-0
-
2279. 匿名 2020/08/21(金) 01:41:40
>>2244
いいねー!
アラサーマンネリとしてはうらやましい限り+2
-0
-
2280. 匿名 2020/08/21(金) 01:42:02
>>2215
近くに高校あるけど、当たり前だけどマスクせずサッカーしてて安心した+0
-0
-
2281. 匿名 2020/08/21(金) 01:42:37
>>2264
アンカ辿ってみて。「自粛しないで経済回せ」発言は強要じゃないって言ってるから。経済回せは私言ってないで論点すり替えたけどね。+1
-1
-
2282. 匿名 2020/08/21(金) 01:42:39
>>2249
ん?最初からケイザイガーさんいた?
そもそもそんな話じゃなかったのに経済回せと強要すなって人が出てきたからだよね。+0
-0
-
2283. 匿名 2020/08/21(金) 01:42:52
>>2266
みんなコロナでイライラしてるんだね。
コロナめー!
+4
-0
-
2284. 匿名 2020/08/21(金) 01:43:15
>>2226
さては、おばはんだな!w
口調からして+0
-0
-
2285. 匿名 2020/08/21(金) 01:43:48
>>2259
コロナはただの風邪!経済回す方が大事!(=政府は正しいんだから従え、批判するな)の人達も、gotoは無理にでも理屈付けて何とか擁護するけど
マスク消毒薬転売OKにした事についてはだんまりだよね
どんなアクロバット擁護もさすがに無理か
+4
-0
-
2286. 匿名 2020/08/21(金) 01:43:56
>>2273
あなたみたいな人ばかりだと穏やかでいいよね。+0
-0
-
2287. 匿名 2020/08/21(金) 01:44:00
>>2215
若い人は無症状や軽症だから?
その人達がコロナまき散らかすよー
+1
-0
-
2288. 匿名 2020/08/21(金) 01:44:02
>>2266
過剰な自粛派は感情的になりやすいから話が通じなくてイラついてるんだろうなぁっていうのはわかる+1
-1
-
2289. 匿名 2020/08/21(金) 01:44:17
>>2275
さらに横w
キレてなくない?
なんでも荒らす~+2
-0
-
2290. 匿名 2020/08/21(金) 01:44:23
>>2281
それ違う人が入ったんじゃない?経済回せ!って断言した人いないじゃん。+0
-0
-
2291. 匿名 2020/08/21(金) 01:44:24
もっと感染者増えないかな
そうしたらもっとみんな気が引き締まるでしょ+0
-1
-
2292. 匿名 2020/08/21(金) 01:44:45
>>2277
うち世帯1000万以上
子供いないから余裕あり
お金がないのに耐えられないから仕事も経済活動も頑張ってる+6
-0
-
2293. 匿名 2020/08/21(金) 01:44:46
コロナさえなければ、今頃テレビでオリンピック中継見たり、夏の旅行楽しんだり、ビアガーデンとかしてるはずだったんだよなあって考えると切ない
自粛には慣れてきたけどちょっと鬱気味かも+3
-0
-
2294. 匿名 2020/08/21(金) 01:44:47
>>2270
大変だね
あした何時から?+0
-0
-
2295. 匿名 2020/08/21(金) 01:44:58
>>2273
ごもっとも+0
-0
-
2296. 匿名 2020/08/21(金) 01:45:07
>>2228
この3ヶ月間のニュージーランドの様子をTVで見たけど、大人数で密集してハカや夜のクラブイベント、芸能人のコンサートで盛り上がって、飲食店も普通に行くし、外をマスク無しで歩いてる人ばかりだった。
インタビューに答えた母子がいて、「そりゃ、
こうなると思った!皆全く自粛すること忘れてるし」と言ってたわ。+2
-0
-
2297. 匿名 2020/08/21(金) 01:45:58
>>2290
横 そこだよ
理解できてないのが謎
よく読んでみて+0
-1
-
2298. 匿名 2020/08/21(金) 01:45:59
>>2294
8時50分に起きて9時から
大変でもないな+0
-0
-
2299. 匿名 2020/08/21(金) 01:46:53
>>2298
すげっ
ショートスリーパーなんだね
+0
-0
-
2300. 匿名 2020/08/21(金) 01:47:25
>>2297
酔っ払ってんじゃない?
まじめにガルしてる人少ないだろうからさ。+1
-0
-
2301. 匿名 2020/08/21(金) 01:47:27
>>2291
全く自粛してないけど何事も過ぎず4ヶ月経過中+1
-1
-
2302. 匿名 2020/08/21(金) 01:47:51
>>2277
つまり自粛して感染拡大を防ぎながら経済活動を両立してるよね。+5
-0
-
2303. 匿名 2020/08/21(金) 01:48:28
>>2275
誰かれかまわずじゃなく、「自粛辞めて経済やめろ」って発言は強要じゃないって発言に対して言ってたんだけどね。この流れで横からの「ないけど」が「私は言ってないけど」って意味だとわかったらそりゃエスパーだわ。+1
-2
-
2304. 匿名 2020/08/21(金) 01:48:45
>>2297
プラス見たら日本語??って思った人多そうだけどなw+2
-0
-
2305. 匿名 2020/08/21(金) 01:49:06
>>2200
皆よく分からずマスクしてる感がある+3
-2
-
2306. 匿名 2020/08/21(金) 01:49:20
>>2303
まあまあ、落ち着いて。+1
-0
-
2307. 匿名 2020/08/21(金) 01:49:23
>>2301
こういう人って石田純一のコロナ関連の言い分や行動にはに共感してる?+1
-0
-
2308. 匿名 2020/08/21(金) 01:49:42
>>2261
巣籠もりなんて不健全
+2
-0
-
2309. 匿名 2020/08/21(金) 01:49:48
>>2274
マスク否定派でも陽性判明したらマスクするのが普通の人
あたおかな患者にあたってしまった看護師さん不運すぎる…+1
-0
-
2310. 匿名 2020/08/21(金) 01:50:23
>>2299
最近寝れなくてねw+0
-0
-
2311. 匿名 2020/08/21(金) 01:50:28
>>2256
やば...お腹減ってきた(´;ω;`)+2
-0
-
2312. 匿名 2020/08/21(金) 01:50:40
こんな時期にフラフラ子供を連れて遊びに出かけたり旅行に行ったりジムに通ったりしている友達とは縁を切った方がいいと思う?+1
-1
-
2313. 匿名 2020/08/21(金) 01:50:50
>>2224
じゃあまだ後遺症が残るかどうかは分からないということだね。
コロナの後遺症は未知。+1
-0
-
2314. 匿名 2020/08/21(金) 01:50:54
>>2304
ガルでプラマイ判断w+0
-0
-
2315. 匿名 2020/08/21(金) 01:51:04
>>2307
沖縄行って飲み屋行ってゴルフしてただけじゃないの?言い分は知らんけど
+1
-3
-
2316. 匿名 2020/08/21(金) 01:51:45
またキレてる人増えてきた。
ここ3日くらいガル見てるけどこの時間帯多いw+2
-0
-
2317. 匿名 2020/08/21(金) 01:51:52
>>2312
私は切らないけど+5
-1
-
2318. 匿名 2020/08/21(金) 01:51:53
>>2261
若者はウェイばかりじゃないけどね
リモート快適って人も少なくないよ+2
-3
-
2319. 匿名 2020/08/21(金) 01:52:35
日本の話じゃないけど生後半年未満の子供がコロナで38人死んでる国があったよ
発展途上国まではいかないけど先進国ではないけどね
気は抜かない方がいいと思う
+0
-0
-
2320. 匿名 2020/08/21(金) 01:53:09
>>2303
両方やめるわけか…平和やん+1
-0
-
2321. 匿名 2020/08/21(金) 01:53:15
>>2290
そう断言した人はいないけど、自粛辞めて経済回せ!発言は「強要じゃない」って言った人はいるよ。強要なのに強要の自覚なかったの?って言ったら「してないけど」と返した人もいたよ。+1
-1
-
2322. 匿名 2020/08/21(金) 01:53:16
>>2200
医療感染者の意見はその反対だけど?
>>大学病院の看護師長は、
「4カ月以上に及ぶ自粛生活と新型ウイルスへの恐怖心で、もともと精神疾患を抱える人、ストレスや環境の変化に耐えられない人は自分に都合のいい解説だけを信じる傾向にある。これが怖いのです。そういう人は無防備になり、大量のウイルスを吸い込むリスクが高い。マスクもソーシャルディスタンスも不要‥‥そんな発言を繰り返すコロナ専門家は、患者の心理がまったくわかっていない」
「コロナ専門家」12人を格付けチェック!「マスク不要」「42万死亡説」の出処(2020年8月9日)|BIGLOBEニュースwww.google.com連日、新規感染者数の最多記録が更新されるなど、終わりの見えないコロナ禍。政府はまったくアテにならず、テレビの専門家のコメントもバラバラ。いったい、何を信じていい…(2020年8月9日 10時0分48秒)
+2
-1
-
2323. 匿名 2020/08/21(金) 01:53:26
>>2319
それが本当ならちょっと怖い+0
-0
-
2324. 匿名 2020/08/21(金) 01:53:57
>>2314
ガル初心者だからごめんねw+0
-0
-
2325. 匿名 2020/08/21(金) 01:54:55
>>2312
私も切らないなージム行ってるし
ていうか人との縁を簡単に切れない…+3
-2
-
2326. 匿名 2020/08/21(金) 01:55:16
>>2318
各々の性格によるよね。カフェとか若い子だらけで超混んでるし+1
-0
-
2327. 匿名 2020/08/21(金) 01:55:33
>>2306
落ち着いてはいるんだけど、この流れが本当にわかってないの?ってビックリしちゃってさ。+0
-0
-
2328. 匿名 2020/08/21(金) 01:55:48
>>2321
してないけど、で違う人なんじゃない?
よくわからなくなるよね。横つけてくれる人もいるけど。+1
-0
-
2329. 匿名 2020/08/21(金) 01:56:39
>>2298
起きてから10分後に仕事ってビックリよ+1
-0
-
2330. 匿名 2020/08/21(金) 01:56:52
極楽山本入院したんだってね。
まだ50代だけど太ってる人はリスク高いのかな?糖尿ではないよね?+1
-0
-
2331. 匿名 2020/08/21(金) 01:57:24
浅草遊びにいったら見事に外国人が少なくなってた。浴衣着た子たちが沢山いて楽しんでたわ+3
-0
-
2332. 匿名 2020/08/21(金) 01:57:32
>>2327
わけわからないよね。
読めば読むほど。
そして怒るのも。+1
-0
-
2333. 匿名 2020/08/21(金) 01:57:58
>>2329
テレワークだろう+0
-0
-
2334. 匿名 2020/08/21(金) 01:57:59
>>2312
少ないお友達がさらに少なく…いやゼロになるんじゃない?コロナにかかるより大ダメージだねw+3
-2
-
2335. 匿名 2020/08/21(金) 01:58:26
観光客今ぐらいに落ち着いてくれたらいいのに
しなちゃんの観光客もういらない+5
-0
-
2336. 匿名 2020/08/21(金) 01:58:42
トピズレすみません
レイラという人の予言YouTubeが気になります
8/21 5:16 神奈川が震源の大地震だそうで断言してます
あと数時間、、一応心に留めておきます
+0
-0
-
2337. 匿名 2020/08/21(金) 01:58:44
>>2315
つまり石田純一の行動に何も疑問を感じたりしないと言うこと?+0
-0
-
2338. 匿名 2020/08/21(金) 01:59:23
>>2326
職場近くのカフェはアラサー以上の中年が多い
若い子達はどこに行ったんだろう…+3
-0
-
2339. 匿名 2020/08/21(金) 01:59:23
>>2328
どうやらそうらしいね。なぜ「自覚無かったの?」という問いに対し「(私は経済回せ発言は)してないけど」で入って来たのか謎過ぎるけど。それじゃ伝わるわけないし。+2
-1
-
2340. 匿名 2020/08/21(金) 01:59:37
>>2214
宗教の勧誘の人のセリフみたい+4
-3
-
2341. 匿名 2020/08/21(金) 02:00:36
>>2339
横
そろそろやめよっか+3
-0
-
2342. 匿名 2020/08/21(金) 02:01:16
>>2277
平均知らないけどこないだの旅行で30万くらい。居酒屋は一回1万未満で週2ほど。コロナ前と変わらず。マスクは洗って使うやつに変えた+2
-0
-
2343. 匿名 2020/08/21(金) 02:01:25
>>2339
そういうこともあるよ。
こういうとこって。
だから落ち着いて。+2
-0
-
2344. 匿名 2020/08/21(金) 02:01:31
>>2322
コロナの女王、岡田の論理を未だに信じる人がいてビックリする
あなたは死亡者のデータを見たことありますか?
それをみてどう思いましたか?
怖いウイルスでしたか?
きっと答えらません
それがメディアに洗脳されたコロナ脳です
精神病です
分からないことあれば聞いてください
データ提示しましょう+4
-0
-
2345. 匿名 2020/08/21(金) 02:01:38
>>2318
若くてリモート快適って心配かも…
出会い大事だし!若い頃は合コンに勤しんだよ
私はもうアラサーババアで結婚もしてるからリモート快適なんだけどさ+3
-1
-
2346. 匿名 2020/08/21(金) 02:02:29
もっともっと経済縮小して静かな日本になってほしいな+0
-1
-
2347. 匿名 2020/08/21(金) 02:02:43
>>2214
ちよw 経済ガーだけど、怖いw
これにプラスつけてる人、大丈夫?
+3
-5
-
2348. 匿名 2020/08/21(金) 02:02:45
>>2183
ウレタンマスクってファッションだからしょうがないよ+1
-1
-
2349. 匿名 2020/08/21(金) 02:02:56
>>2329
こんな時間までダラダラ起きてる明日仕事の人ってリモート多いんじゃね?+0
-0
-
2350. 匿名 2020/08/21(金) 02:03:23
>>2305
暑いから外でははずして店内は一応つけてる。+1
-0
-
2351. 匿名 2020/08/21(金) 02:03:44
>>2345
まじ快適
トレーニングできるのが嬉しい+3
-0
-
2352. 匿名 2020/08/21(金) 02:03:54
>>2347
何が問題かご指摘ください
一応経営学修士も持ち合わせてますので、
マクロ、ミクロ観点から具体的に説明しますよ+7
-5
-
2353. 匿名 2020/08/21(金) 02:05:02
コロナ怖い人って本当にいるんだ🤧w+3
-1
-
2354. 匿名 2020/08/21(金) 02:05:22
>>2351
トレーニング?
リングフィットとかそっち系ですか?+0
-0
-
2355. 匿名 2020/08/21(金) 02:05:54
ただの風邪でしょこんなの+4
-3
-
2356. 匿名 2020/08/21(金) 02:06:13
>>2348
そなの?
あれ1番通気性いい気がする。
店、電車でするくらいだしあれ使える。+0
-1
-
2357. 匿名 2020/08/21(金) 02:06:28
>>2265
思ってるほど高くないよ
+0
-0
-
2358. 匿名 2020/08/21(金) 02:06:43
>>2352
単に論調が怖いw
普通にリアルで言われたら、ひく+2
-5
-
2359. 匿名 2020/08/21(金) 02:06:57
>>2354
筋トレだよ。+1
-0
-
2360. 匿名 2020/08/21(金) 02:07:44
なんで高齢品のために、若者の財産を犠牲にするの?
道徳振りかざして、若者を血塗れにしてもいいんでしょあなた達は
これだから日本は発展しない
そう、今後も![東京都で新たに339人の感染確認 5日ぶり300人超 重症者は4人増え36人]()
+0
-0
-
2361. 匿名 2020/08/21(金) 02:08:11
>>2312
フラフラって書いてる時点で悪感情丸出しだから縁きるのがお互いの為よ+3
-0
-
2362. 匿名 2020/08/21(金) 02:08:22
>>2352
説明してみてー!+2
-1
-
2363. 匿名 2020/08/21(金) 02:09:50
おフランス![東京都で新たに339人の感染確認 5日ぶり300人超 重症者は4人増え36人]()
+2
-0
-
2364. 匿名 2020/08/21(金) 02:10:37
>>2363
素晴らしい❗+1
-0
-
2365. 匿名 2020/08/21(金) 02:10:41
>>2352
経済系の人が言いそうだわ。
でも本当に寿命とコロナ死平均年齢同じくらいだよね。
変わらない。+2
-2
-
2366. 匿名 2020/08/21(金) 02:10:51
>>2358
これが感情論なんですよ
底辺は何が問題か指摘できないんです
合理性に欠けた、感情論で、論議に歪みを生じさせる
それが今のポピュリズムで形成された国家運営なんです
民主主義って、知ってますか?
あなたのような人を無視するためにあるんです
碩学をもつ方が決めるのを邪魔しないでほしい
なぜヒトラーが民衆から支持されたのか?
あなたのように馬鹿な人が多いからですよ
身の程を知りなさい![東京都で新たに339人の感染確認 5日ぶり300人超 重症者は4人増え36人]()
+3
-4
-
2367. 匿名 2020/08/21(金) 02:11:05
>>2363
パーティー行きたいわ。+3
-1
-
2368. 匿名 2020/08/21(金) 02:12:03
>>2362
ですから、何を問題としてるか、指摘して下さい
反証します+1
-0
-
2369. 匿名 2020/08/21(金) 02:12:42
>>2363
なんか汗臭そうだし地面固そうだし+1
-0
-
2370. 匿名 2020/08/21(金) 02:12:47
>>2342
自粛してるうちと同じくらいだ。何に使ってるかが違うんだね。+2
-0
-
2371. 匿名 2020/08/21(金) 02:13:02
>>2363
オランダもマスクやめたよ+0
-0
-
2372. 匿名 2020/08/21(金) 02:13:28
>>2360
感染者数が増えたら
高齢者が怖がって自粛しちゃうのよ
高齢者には危険なウイルスだから。
若者だけじゃ経済回らないから経済まで悪化しちゃってる。
ガルでは感染者数=100恐怖で見ない人も多いけど、高齢者はわからないからね
+2
-0
-
2373. 匿名 2020/08/21(金) 02:14:12
>>2370
外食週2回なら自粛してる、に入らないよ+0
-0
-
2374. 匿名 2020/08/21(金) 02:14:20
>>2312
子供や自分に感染するリスクが高くなりそうだから会わないようにする。+1
-0
-
2375. 匿名 2020/08/21(金) 02:14:28
>>2356
マスクしないよりは飛沫防止になってるよ。+0
-0
-
2376. 匿名 2020/08/21(金) 02:15:13
>>6
でたーーー
覚悟しないと
2週間後
ツケ
毎度お馴染み+11
-5
-
2377. 匿名 2020/08/21(金) 02:15:19
>>2366
感情論ねー
別に内容に問題あるとは言ってないけど、どっちが感情論なんだかw+3
-2
-
2378. 匿名 2020/08/21(金) 02:15:40
>>2373
あ、ごめん。内訳じゃなく金額ね。外食はほぼしてない。+0
-0
-
2379. 匿名 2020/08/21(金) 02:16:21
>>2189
スーパーの店員さんのゴム手袋なんてもう最悪
いつ交換してるのかな+0
-5
-
2380. 匿名 2020/08/21(金) 02:17:09
>>2378
自粛組だけど何にそんなに使うの?+0
-0
-
2381. 匿名 2020/08/21(金) 02:17:27
>>2345
すごい関係ないんだけど、アラサーってもうババアなの…?+0
-0
-
2382. 匿名 2020/08/21(金) 02:17:34
>>2216
あなた日本人?+0
-0
-
2383. 匿名 2020/08/21(金) 02:18:05
>>2377
3度目の指摘です
何を問題視してるか、ご指摘ください+2
-2
-
2384. 匿名 2020/08/21(金) 02:18:27
>>2368
じゃさ、
経済学を学んだ人がただの風邪と思うのはどうして?+2
-0
-
2385. 匿名 2020/08/21(金) 02:18:27
>>2370
夫婦二人だから安く済んでるよ
+0
-0
-
2386. 匿名 2020/08/21(金) 02:19:28
>>2379
ゴム手でアルコール除菌してるぽい
動作変えるごとにシュッてしてるのみた
してない人いるだろうけど+1
-0
-
2387. 匿名 2020/08/21(金) 02:19:38
>>2383
だから、論調だってばw
+0
-1
-
2388. 匿名 2020/08/21(金) 02:19:43
>>2381
横
アラサーの時にはババアと思ってたよ
+0
-0
-
2389. 匿名 2020/08/21(金) 02:20:20
本当に怖い。普通ウィルスって夏場は活動活発じゃないのに、この暑さでも感染者増加し続けるってなぜ?永遠にコロナウィルスは終わらないんじゃないか、コロナ前の世界はもう戻ってこないんじゃないか…そう考えると怖くなるんですが、本当にいつか終わるのでしょうか?二度と海外に行けない可能性ってあるんでしょうか?+7
-1
-
2390. 匿名 2020/08/21(金) 02:20:26
>>2387
の、どこ?
感性で言ってますか?+1
-1
-
2391. 匿名 2020/08/21(金) 02:21:22
>>2384
横だけど経済の専門家この話よくしてるからTwitter見てもいいのかも。統計のデータ、グラフ載せてたりする。+1
-1
-
2392. 匿名 2020/08/21(金) 02:21:59
>>2387
横のガル○だけど、これが女なんだよ
論理じゃなくて、相手の人格や知性が怖くてまともに話し合えない
これだから日本の女は程度が低いんだ+2
-2
-
2393. 匿名 2020/08/21(金) 02:22:01
>>2352
ダラダラと患者を蔓延させるよりも短期に患者減らすような政策した方が経済効果で20兆円分マイナスが減ると日本のシンクタンクが発表してたけど、あなたは「コロナは風邪」の人だからコロナによる経済損失関係ないですよね。
感染拡大して全く問題無しとしてる「コロナは風邪」の人でしょ?+2
-1
-
2394. 匿名 2020/08/21(金) 02:22:04
>>2388
えー、ババアの自覚なく普通に過ごしてた…。
コロナのせいで現実を知ってしまった+0
-0
-
2395. 匿名 2020/08/21(金) 02:23:04
>>2384
基礎疾患持ち及び、高齢者にのみの死亡が確認されているためです+3
-3
-
2396. 匿名 2020/08/21(金) 02:23:09
なんか勝間さんみたいのいるなー+0
-0
-
2397. 匿名 2020/08/21(金) 02:23:58
>>2380
嘘です。そんなに使ってない。ごめんなさい+0
-2
-
2398. 匿名 2020/08/21(金) 02:24:35
>>2390
繰り返すけど、単に論調が怖いw
普通にリアルで言われたら、ひく
頭良いなら私が言ってる意味、わかるでしょw
普段何してる人?興味ある!
友達いる?友達にも同じ論調で同じ内容話すの?
+3
-5
-
2399. 匿名 2020/08/21(金) 02:24:55
>>2380
ガーデニングw苗やら土やら肥料やらに拘るとお金がすっ飛んでくんだわ。旦那も趣味になんやかんやつぎ込んでるし、後は外食しない分、家で贅沢してるから食材が跳ね上がってる。あ、そういや旅行は県内で行ったよ。+0
-1
-
2400. 匿名 2020/08/21(金) 02:25:27
>>2352
横からごめんなさい
あなたはコロナは怖くないと思いますか?
私は、かかったら重症化するリスクが普通の人よりあるんですが、その場合この先ずっと自粛みたいに生きていかなきゃいけないでしょうか?
頭よさそうなので、ひとつの意見として参考にさせて頂きたいです+0
-0
-
2401. 匿名 2020/08/21(金) 02:25:36
>>2397
って、あなた誰www+3
-1
-
2402. 匿名 2020/08/21(金) 02:26:26
>>2337
しない+0
-0
-
2403. 匿名 2020/08/21(金) 02:26:30
>>2366
横だけど、
民主主義の定義を間違えてるよ。
ご立派な経済学を学んだ人とは思えません。+3
-1
-
2404. 匿名 2020/08/21(金) 02:28:12
>>2398
申し訳ないがわからない
臭い物に蓋をする空気を正当化するように思えるだけです
私は臭い物と思いませんが
キャッキャしてるキラキラ系?の女性とは接点ないので
職は外資系トレーダー兼アナリストしてます
明日はマーケットのお休みですね+3
-6
-
2405. 匿名 2020/08/21(金) 02:28:19
>>2389
平和ボケすぎ。もう海外行けるわけない。
ワクチンはできない。治療薬もない。それはこの先も99%変わらない。無理に決まってるでしょ。
それに、行けたとしても、差別とか怖いよ。どこの国行きたいか知らないけど、欧米、ヨーロッパとかはアジア人差別ひどくなると思うよ。
+6
-2
-
2406. 匿名 2020/08/21(金) 02:28:36
>>2395
重症者が右肩上がりになっても
どの程度までなら医療崩壊しないの?
+2
-0
-
2407. 匿名 2020/08/21(金) 02:29:02
>>2395
何それ?
そんなのみんな知ってるけど+2
-1
-
2408. 匿名 2020/08/21(金) 02:29:54
>>2399
えー!そういうのまでいれたらもっといくよ。
あくまで旅行と外食の話の値段
+1
-0
-
2409. 匿名 2020/08/21(金) 02:30:55
>>2403
だから具体的に何が問題か指摘してくださいよ!!!
何度も言ってるじゃないですか!!!!!
民主ってのは、国民アンケートでもないし、メディアの誘導でもないんです
選ばれた碩学あられるエリートが裁定するんです
+0
-6
-
2410. 匿名 2020/08/21(金) 02:31:03
>>2398
横
あなたも結構すごいで。
友達いる?とか息巻いて。
引いてる人いると思う。+4
-1
-
2411. 匿名 2020/08/21(金) 02:31:45
>>2408
あ、そうなんだ。それは失礼しました。+0
-0
-
2412. 匿名 2020/08/21(金) 02:32:10
>>2405
コロヒスすぎ。永遠に海外行けないなんてあるわけないだろ。来年オリンピックもあって、外国から人来ますけどー??永遠に薬できないって決めつけるのはなんで??未来人とかやめてね。寒いからw+2
-4
-
2413. 匿名 2020/08/21(金) 02:32:33
>>2407
知ってる知ってないの話じゃない気が…+1
-0
-
2414. 匿名 2020/08/21(金) 02:32:52
日本では1日平均3800人が死亡している。
その内コロナの死亡者が10人としても割合は0.3%にも満たない。
+3
-0
-
2415. 匿名 2020/08/21(金) 02:33:15
>>2404
アホな方いるので、予めお伝え申し上げますが、私はNYロンドン時間の労働者ですので、この時間は普通に起きてます
今会社です+2
-2
-
2416. 匿名 2020/08/21(金) 02:34:12
>>2404
なるほど…周りにキラキラがいないから引かれる意味がわからないのか
臭い物までは思ってないよ
+2
-0
-
2417. 匿名 2020/08/21(金) 02:35:23
頭良さそうな人きたら自粛派が黙っちゃったよ+4
-0
-
2418. 匿名 2020/08/21(金) 02:35:44
>>2412
横からですが、
オリンピックは来年開催は無理では?
コロナの世界情勢をみるに。
+6
-2
-
2419. 匿名 2020/08/21(金) 02:35:44
>>2415
普通にカッコよくて憧れる
いわゆるウォールストリートで働いてるんですよね+3
-1
-
2420. 匿名 2020/08/21(金) 02:36:11
>>2406
医療崩壊とは、指定感染症の範囲で、指定された医療機関の容量の問題です
分かりやすく例えます
新コロより死亡者の多いインフルエンザを指定感染症とすれば、今以上の崩壊が起きてます+6
-2
-
2421. 匿名 2020/08/21(金) 02:36:30
>>2410
そだね、ごめんねー
+0
-0
-
2422. 匿名 2020/08/21(金) 02:36:33
>>2416
どうやらひいてるのは貴方だけのもよう+3
-1
-
2423. 匿名 2020/08/21(金) 02:36:53
>>2407
具体的な指摘をして下さい+1
-0
-
2424. 匿名 2020/08/21(金) 02:37:09
>>2418
来年やらなきゃいつやるんですか?
オリンピックは中止にできないですよ?決まりで。
観光客も来るし、そのために今ワクチン超特急で作ってるわけで。開催中止はないです。+0
-3
-
2425. 匿名 2020/08/21(金) 02:37:32
>>2418
欧米、欧州は収束傾向だよ。下手にロックダウンした国は方向転換しないと無理っぽい
+4
-1
-
2426. 匿名 2020/08/21(金) 02:37:51
>>2417
いいね!
自粛派はそろそろおねむじゃない?
起きてるのリモートのおばさんが多そう+1
-0
-
2427. 匿名 2020/08/21(金) 02:38:08
>>2419
いいえ、日本でもnyロンドンのマーケットは入れます+2
-0
-
2428. 匿名 2020/08/21(金) 02:38:45
>>2380
ガーデニングでかなりお金使った。暇だし20種類の植物を20株ずつとか。
あと1月から備蓄で一部屋潰れたし、子供のオンライン家庭教師で月3万、ウイルス除去出来る高性能フィルターの空気清浄機2台、スーパーに行くより割高な食品配達の定期契約とかね。
お取り寄せでウニとかイクラとか有名店のお菓子とか。+1
-2
-
2429. 匿名 2020/08/21(金) 02:39:19
>>2417
頭よさそうな人きてるの?+2
-0
-
2430. 匿名 2020/08/21(金) 02:40:19
>>2420
インフルって入院数多いの?死亡100~3000人って今日ガルちゃんで見たけど+1
-0
-
2431. 匿名 2020/08/21(金) 02:40:52
会社から強制もされてない、症状も無いのにあえてPCR受ける人って何なんだろう
+2
-0
-
2432. 匿名 2020/08/21(金) 02:40:58
>>2428
ガーデニングで散財してるお仲間発見!暇だからついついやってまうよねw+0
-1
-
2433. 匿名 2020/08/21(金) 02:41:28
>>2420
あなたの言ってることが正しい。
コロヒスがすぎる人が多い。何をそんなに恐れるのか?インフルエンザと変わらない、むしろそれより軽いくらいかもしれない。メディアが感染者ばかり報じて、回復者を報じないのが悪い。
コロナで人は死にません。
死ぬのはお年寄り、基礎疾患もち。コロナで死んでしまった人は、インフルエンザで命を落とす可能性だって高かったわけで、どっちが先かの話だけ+5
-8
-
2434. 匿名 2020/08/21(金) 02:41:55
>>2409
興奮しないでね
民主主義の定義を間違えてますよ+3
-0
-
2435. 匿名 2020/08/21(金) 02:42:34
>>2428
お取り寄せ系はさらに増えてそう。自粛後
うちもよくしてる。+2
-1
-
2436. 匿名 2020/08/21(金) 02:43:31
>>2420
全国一斉休校の効果と、3月の大阪北海道東京の自粛要請は効果あったんかな?
+1
-0
-
2437. 匿名 2020/08/21(金) 02:44:14
まあ経営学修士も、外資トレーダーも嘘ですよwww
分かりますか?
こんな嘘に騙される程度、それがあなた方です
肩書きさえあれば、なんでも信じるんですか?
安易な罠にはまりましたね
私は論理で話をしましょうと言ってるだけです
ですから、問題視してる点については、反証させていただきますよ
投資家であるのは、間違いないし、資産家ニートなのは間違いないんですけど、私はただの個人投資家です+1
-2
-
2438. 匿名 2020/08/21(金) 02:44:55
>>2437
ワロタけど誠意がある+1
-0
-
2439. 匿名 2020/08/21(金) 02:45:16
>>2420
指定感染症にした理由と、外さない理由を教えてもらえますでしょうか?+0
-0
-
2440. 匿名 2020/08/21(金) 02:46:35
「コロナ倒産 都内100件超」の記事を読んでヘコむ。飲食店が最多で、春先まで繁盛してた店が次々と閉めているのだ。当然私やあなたが通ってた店も含まれ、店主の笑顔が「ヘイお待ち」の声とともに甦る。隣や前に座った友も思い出され、交わされた会話のあれこれが脳内を駆け巡る。常連の顔も懐かしい。 立川談四郎+2
-0
-
2441. 匿名 2020/08/21(金) 02:47:06
>>2059
8月だけで東京の熱中症100人以上死んでる
老人は何で冷房つけないのかなあ?
世田谷で一人住まいのうちの母も、冷房ケチる。
高い寿司喰ったり、高い習い事とか行ってるくせにエアコンをなぜケチる?+15
-1
-
2442. 匿名 2020/08/21(金) 02:47:38
>>2438
更にごめーん!
ホントはキャバなんだよね
Twitterの拾いネタをコピペしたの+0
-0
-
2443. 匿名 2020/08/21(金) 02:47:55
>>2428
めっちゃ贅沢してるのね
+2
-1
-
2444. 匿名 2020/08/21(金) 02:48:26
>>2437
騙された人なんかいないよ
みんなにからかわれてたじゃん+5
-0
-
2445. 匿名 2020/08/21(金) 02:48:30
今までの最速のワクチンはオタフクで4年です。未知で変異しやすく種類が多いワクチンが数ヶ月で出来るなんて奇跡ですよね
+3
-0
-
2446. 匿名 2020/08/21(金) 02:48:40
>>2442
なーんだ
謎が解けると思ったのに
てか、プラスした人かわいそうだよ+1
-0
-
2447. 匿名 2020/08/21(金) 02:50:03
>>2427
知らなかったです!ありがとうございます
+0
-0
-
2448. 匿名 2020/08/21(金) 02:50:10
こりゃ旅館もどんどん潰れてくわ
+1
-0
-
2449. 匿名 2020/08/21(金) 02:50:41
>>2437
いや、騙されてないけど。頭よさそうな人来たってあったけど誰のこと?と思ったよ。+3
-0
-
2450. 匿名 2020/08/21(金) 02:51:43
>>1501
プラス10人くらいと言ってたけど。
そんなことより、なんで国にいちいち歯向かおうとするんだろうと思う。
都民の私は東京応援してるけど、時々、なんで?と思う
+2
-0
-
2451. 匿名 2020/08/21(金) 02:52:30
>>2448
行きつけの旅館、緊急事態宣言あたりから部屋を少し閉めててgotoあたりで元に戻したみたい+2
-0
-
2452. 匿名 2020/08/21(金) 02:53:42
>>2442
あんたキャバよりホステスのほうが向いてる。
情報を拾って、コピペでもそれっぽくできてたし
頭の回転もいいんじゃないの。愛嬌もありそうだし。キャバで稼げないからってパパ活とかで身を売るとかしないでね。+2
-2
-
2453. 匿名 2020/08/21(金) 02:54:25
>>2439
えーと、嘘の肩書きの私です
ですが。ちゃんと見解には答えます
指定感染症にした理由
→ 毒性の強い変異型のものに踊らせれ、日本国内のものと同一視した
→ 国民に煽られ、新コロ感染のテロリズムを国家として黙認した
→未知という言葉におどらされた(今5000種あります、ソース欲しければ言ってください。逃げずにちゃんと提示します)
外さない理由
→ 知見の無い方々へ、広くある感染症死を許容すると言えない政権体制
→新コロに限らず、死を一定に受け入れてきたのが今の世であると言えない
もし、新コロを脅威と感じるのであれば、ガスマスクして下さい
しないですよね、心の中で毒性の弱いウイルスと分かっているのですから+4
-10
-
2454. 匿名 2020/08/21(金) 02:54:59
>>2415
ニューヨークとロンドンて時間帯が違うんでは?+4
-0
-
2455. 匿名 2020/08/21(金) 02:55:25
>>2424
オリンピックは無理じゃない?
無観客じゃやらないって言ってるし、つまり無理ってことなんだよ。ワクチンが来年までにできるとは思えない。+3
-0
-
2456. 匿名 2020/08/21(金) 02:56:00
>>2437
なんなんだ?この人。
何が言いたいのかよく分からない。+5
-0
-
2457. 匿名 2020/08/21(金) 02:56:13
>>2453
私あなた好きかも+1
-5
-
2458. 匿名 2020/08/21(金) 02:56:30
小学生くらいの子供いる人、野外で周りに人がいないときはマスク外していいよって教えこんでください。1人で顔真っ赤にして歩いてる子が結構いて可哀想+4
-0
-
2459. 匿名 2020/08/21(金) 02:57:05
私も女だけど女ばっかり集まるサイトで馬鹿な書き込みばかり
まあみんなもれなくて学歴なんだろうね
書いてることがバカすぎて臭+2
-0
-
2460. 匿名 2020/08/21(金) 02:57:12
>>2453
先に提示しときます
GISAID - Next hCoV-19 Appwww.gisaid.orgGISAID - Next hCoV-19 AppGenomic epidemiology of hCoV-19About usMissionHistoryGovernancePublic-Private PartnershipsGrantsTechnical PartnersAcknowledgementsImprint / PrivacyDatabase FeaturesFluSurver AppNextflu AppNext hCoV-19 AppSubmitting Data t...
話変わって申し訳ないが、後遺症厨さんいらっしゃれば、何かをご提示くださいませ
反証します
病み上がりであると+0
-5
-
2461. 匿名 2020/08/21(金) 02:57:23
>>2455
だから。オリンピックは開催しなきゃいけない決まりがある。ルールってわかりますか?+0
-3
-
2462. 匿名 2020/08/21(金) 02:57:42
私は本気のコロナ脳よりも、別にコロナが大した事ないのは分かってる、大袈裟だとか言いながらも「マナーだから」と社会派気取ってマスクして安全な大多数に所属しながら矛盾を発信し続ける中途半端な人たちが1番コロナ禍に加担してると思ってる。+0
-6
-
2463. 匿名 2020/08/21(金) 02:57:51
>>2453
外さない理由が、いまいち??なんだけど
指定感染症はいずれ外れるから、その時の理由を政府や指定感染症賛成した専門家はどう説明するんだろ?+2
-0
-
2464. 匿名 2020/08/21(金) 02:59:00
>>2322
この記事やばいね。
二木とか最悪やん。星3つって。
当たり障りのないこと、のらりくらり発言して出演料もらって喜んでるだけの人。
+3
-0
-
2465. 匿名 2020/08/21(金) 02:59:07
>>2459
もれなくて学歴だよ
あなたも私も低学歴よ
+0
-1
-
2466. 匿名 2020/08/21(金) 02:59:15
>>2460
新型コロナはHIVに通ずるところがあると、HIVを発見した研究者が言ってるので、誰になんて言われても、今後5-10年はかからないようにして、他の人の経過を見ないと今は分からない!+10
-3
-
2467. 匿名 2020/08/21(金) 03:00:00
>>2463
いまいち?とは?
具体的に忌憚なくご指摘下さいませ
言葉強くても構いません
+1
-0
-
2468. 匿名 2020/08/21(金) 03:00:02
>>2461
そんなルールどこにあんの?なんでそんなオリンピックにこだわってるの?+1
-0
-
2469. 匿名 2020/08/21(金) 03:00:45
>>2466
そ れ が 本 当 な ら 怖 い+2
-1
-
2470. 匿名 2020/08/21(金) 03:00:48
>>2461
ひるおびに出ているメダリストの柔道家の女子ですね?+3
-0
-
2471. 匿名 2020/08/21(金) 03:01:56
>>2466
RNA型の、新コロと同一視する誤検知のことですか?
もうちょっと具体的ご指摘下さい+0
-4
-
2472. 匿名 2020/08/21(金) 03:02:17
コロナはただの風邪である、とは、思えない。
そう言うから、みんな予防しなくなる。
やっぱり密な所ではマスク必要だし、多人数で飛沫飛ばしての外食は避けて、こじんまりと外食も楽しみたい。
予防しなくてもいいような言い方はしない方がいい。+9
-3
-
2473. 匿名 2020/08/21(金) 03:02:47
>>2467
指定感染症は早く外してほしいんだよね
でも、あなたが言う「外さない理由」が正しいなら、政府はその姿勢を貫きとおすのかな?
どうやって理由つけて解除するんだろ?
+2
-0
-
2474. 匿名 2020/08/21(金) 03:03:11
さっき、有吉のテレビで
パンサーの菅さんがガルを見てることがわかった。
結構、男で見てる人多いと思うよ。
主婦たちの意見を参考にしようと思って。
そして、見てるうちに何か言いたくなっちゃって書きこんでいるやついそうだな。+1
-1
-
2475. 匿名 2020/08/21(金) 03:03:13
>>2466
無理無理+0
-0
-
2476. 匿名 2020/08/21(金) 03:03:22
>>2466
そういえば感染初期だったかな。
エイズ治療薬を感染者に投与したら症状が改善された例があったよね。
この研究は進んでいるのかしら。
母子感染はしないと言われたり、した例もあるしよくわからないんだよね。
情報が沢山ありすぎで逆に混乱を招いているなといつも思う。+3
-0
-
2477. 匿名 2020/08/21(金) 03:03:58
>>2453
私はこう思う!って範囲を出てないんだねー
でもまぁ専門家じゃないただの素人だしこんなもんよね+3
-1
-
2478. 匿名 2020/08/21(金) 03:04:06
>>2453
ニートでしょ?
外に出ない人から
感染症や経済について語られたくないわ+3
-1
-
2479. 匿名 2020/08/21(金) 03:04:32
>>2474
なるほど
男だろうなって、たまにいるよね+3
-0
-
2480. 匿名 2020/08/21(金) 03:04:34
あれだけ回復してる芸能人の束見てもずっと怖がっていられることが理解不能
+0
-3
-
2481. 匿名 2020/08/21(金) 03:05:32
コロナの後遺症が全員にあるとは言わないけど 私の周りのコロナ感染者階段の上り下りきつそうにしてるよ
正常時に戻らないんだって+4
-0
-
2482. 匿名 2020/08/21(金) 03:05:33
>>2460
風邪で血栓が出来る割合を把握していますか?
+0
-0
-
2483. 匿名 2020/08/21(金) 03:05:57
>>2457
人は騙された時に傷つかないよう肯定する
ありがとう+0
-1
-
2484. 匿名 2020/08/21(金) 03:06:03
>>2476
あったあった。エイズ治療薬はコロナによる免疫の暴走を抑える為に有効とか何とか言われてたよね。あの後どうなってるんだろう。+2
-0
-
2485. 匿名 2020/08/21(金) 03:06:12
>>2473
海外のノーマスクデモ然り、許容の動向に則るでしょう
例えばドイツのノーマスクデモ130万人(メディアはっぴょ2万人ですが虚偽であると立証可能、欲しければソース提示しますので言ってね)
スウェーデンのノーマスク体制の国際的模範がそれにあたります+1
-1
-
2486. 匿名 2020/08/21(金) 03:06:17
>>2468
観戦チケットが当たった人なんじゃない?
だからやってもらわなきゃならない!何がなんでも!みたいな感じなのかな。+1
-0
-
2487. 匿名 2020/08/21(金) 03:07:37
>>2452
キャバ嬢ってのも嘘くさくないか?+1
-0
-
2488. 匿名 2020/08/21(金) 03:07:43
>>2453
うるせーキャバ嬢+1
-1
-
2489. 匿名 2020/08/21(金) 03:07:49
>>2481
「ストレス不安があると自然免疫は低下し、ウイルスに感染しやすくなる。コロナ不安や経済危機自体が免疫を劣化させる」
新型コロナ、首都圏ほぼ全員“既感染”!? 日本の死者が欧米より少ない要因の一つに「集団免疫説」 専門家の新抗体検査で明らかに - ZAKZAKwww.zakzak.co.jp新型コロナ、首都圏ほぼ全員“既感染”!? 日本の死者が欧米より少ない要因の一つに「集団免疫説」 専門家の新抗体検査で明らかに - ZAKZAK新型コロナ、首都圏ほぼ全員“既感染”!? 日本の死者が欧米より少ない要因の一つに「集団免疫説」 専門家の新抗体検査で明...
+0
-1
-
2490. 匿名 2020/08/21(金) 03:08:00
>>1155
確かに東京は日本の中心でそのおかげで成り立ってるのが日本だけれど、東京に行く選択をしなかった人に罪があるわけでもないし、全国でそれぞれ生活して生きているわけだから自分の住んでる土地やその周りのことについて報道してほしいと願うのは当たり前だと思う。東京のおかげでお金はあるけど、お米や農産物、その他のものも地方にたくさん貰ってるよ。仕方がないよって突き放すこともないんじゃないかな。
どちらもないと成り立たない。
東京出身者だけど。+7
-1
-
2491. 匿名 2020/08/21(金) 03:08:46
>>2487
人気の人ならアフターかプライベートで飲んで潰れてる時間だろ。+2
-0
-
2492. 匿名 2020/08/21(金) 03:09:15
>>2460
風邪で抜毛が起こる後遺症があると?
>>自治医科大学付属さいたま医療センター・讃井將満教授:
実際に起こっていますね。私の知っている範囲でも、友人で2人いらっしゃるんで、(抜け毛に)なるんだと思います。(感染による)ストレスも強く受けている。体自体にも侵襲(しんしゅう)と言いますけど、ダメージがありますから、それによる影響ではないでしょうか
讃井教授によると、感染による心理的ストレスだけでなく、ウイルスによる肉体的なダメージも影響し ている可能性があるという。
ハリウッド女優も告白 コロナ後遺症なのか?新型コロナから回復した後、抜け毛に悩まされる女性続出(FNNプライムオンライン) - Yahoo!ニュースnews.yahoo.co.jp8月18日の時点で、新型コロナウイルスの感染者は全国で合わせて 5万7696人。一方、これまでに4万2284人が退院や療養解除となり、日常生活を取り戻している。
+1
-1
-
2493. 匿名 2020/08/21(金) 03:10:01
>>2472
極端過ぎるんだよね。
コロヒスもただの風邪言う人も。
コロナなんか感染しないに越したことないんだから、
予防はして、あなたの言うこじんまりと行動したらいいと思うわ。+6
-0
-
2494. 匿名 2020/08/21(金) 03:10:01
>>2485
え、いや、日本の話で
指定感染症を外せない理由を頼む…
やっぱりもういいやw
+2
-1
-
2495. 匿名 2020/08/21(金) 03:10:28
知り合いの不動産屋さんのご主人が人工透析をしていたのですが、最近亡くなりました。コロナで通院しにくくなったのも一因だと、奥様が話してくれました。実際どうなのかはわかりませんが、多少なりとも影響はあったかと思います。+2
-0
-
2496. 匿名 2020/08/21(金) 03:10:32
>>2473
追記します
whoのマスク着用推奨は、日本の被害を鑑みたものですね
まず、そこの論理的な立証要素は提示されておりません
まあ、マスクは無意味です
あなたが隙間のないマスクしても、蒸気が出ます。
上記の中にウイルスは含まれます
でも発症してない方にはほとんど含まれません(一定には含まれます)
ですが、本ウイルスは免疫力に依存します
他者のウイルスや細菌を共有して、自己の免疫力を子供の頃から高め、今も維持する
それが健全です
違うなと思えば忌憚なくご指摘下さい+1
-3
-
2497. 匿名 2020/08/21(金) 03:11:00
>>2486
希望者に払い戻しありますよね。+0
-0
-
2498. 匿名 2020/08/21(金) 03:11:22
>>2466
新型コロナとは感染の仕方が全く異なるけど、HIVって死者がものすごく多いの初めて知ったよ
Global Deaths Due to Various Causes and COVID-19 | Flourishpublic.flourish.studioA visualisation made with Flourish – the platform for interactive data visualisation and storytelling
+2
-0
-
2499. 匿名 2020/08/21(金) 03:11:35
>>2448
大人しく自粛してる人多いんだなぁ+0
-0
-
2500. 匿名 2020/08/21(金) 03:12:28
>>2494
分かりやすくいいます
愚民によるポピュリズム化してるからです
これで分からないならば、
もっと、分かりやすく言います
感情論ヲを主軸に置いて、生命を優先する道徳に、論理を通用させないからです。+1
-6
コメントを投稿する
トピック投稿後31日を過ぎると、コメント投稿ができなくなります。削除すべき不適切なコメントとして通報しますか?
いいえ
通報する